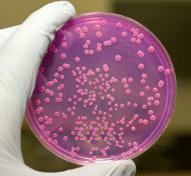

![]()



Pressostato compatto con indicazione a 360° della condizione d’intervento

Design compatto
Sistema di adattatori igienici
www.vega.com/vegabar 15 cm

256 colori
Selezionabile individualmente:
Misura in corso Commutazione del sensore Malfunzionamento nel processo
E’ uno strumentino portatile che indica in tempo reale la presenza di sporco organico sulle superfici o in acqua, attraverso la rilevazione di ATP e suoi derivati
Kairosafe offre il Lumitester Smart abbinato ai tamponi Lucipac A3, con i quali si preleva il campione dalle superfici o dall’acqua. Il test, rapido e preciso, è utilizzabile per il controllo della sanificazione in tutti gli ambiti, alimentare, sanitario, HO.RE.CA, industriale ecc
Per ordinare:
codice 61324: Lumitester Smart
codice 1702671-60361: Lucipac A3 Surface, tamponi codice 1702672-60365: Lucipac A3 Water, tamponi



Tamponcino per verificare la presenza di residui proteici sulle superfici. Il risultato viene valutato visivamente poiché il viraggio da giallo a verde indica la presenza di proteine. I 2 kit disponibili si differenziano per la sensibilità.
Per ordinare:
codice CC4008.0050: Pro-Check 20 µg codice PC002.0020: Pro-Check SensiPLus 2 µg

Contatta il nostro team
040 299502-2907149 info@kairosafe.it chatta con noi su www.kairosafe.it
Tecniche
Novità

Sostenibilità ed imballaggi: il nuovo regolamento
imballaggi e i rifiuti di imballaggio
La strada dei risparmi
e del riuso dell’acqua
Le sfide della transizione ecologica ed energetica


Il valore dell’agroalimentare Diletta Gaggia
BEST PRACTICE
Come gli standard proteggono le aziende Paolo Bersighelli
ABBIAMO PARLATO DI
CEREAL DOCKS pag. 28 www.cerealdocks.it
CSB-SYSTEM pag. 57 www.csb.com
EMERSON pag. 29 www.emerson.com
IFM ELECTRONIC pag. 31 www.ifm.com
INPEST pag. 37 www.inpest.it
LORYMA pag. 31 www.crespeldeitersgroup.com/loryma
NORD DRIVESYSTEMS pag. 30 www.nord.com
REALMAN pag. 29 www.realman-robotics.com
RWC pag. 30 www.rwc.com
Immagini Shutterstock
Produzione
Antonio Iovene a.iovene@lswr.it Cel. 3491811231
Direttore Commerciale
Costantino Cialfi c.cialfi@lswr.it tel. 3466705086
Traffico Ilaria Tandoi i.tandoi@lswr.it
ABBONAMENTI www.quine.it abbonamenti.quine@lswr.it Tel. 02 864105 www.alimentinews.it
Costo copia singola: € 2,80
Abbonamento annuale Italia: € 40
Stampa
New Press Edizioni S.r.l. Lomazzo (CO)
Quine Srl
Produzione & Igiene Alimenti - Bimestrale Rivista ufficiale del Consiglio dell’Ordine Nazionale dei Tecnologi Alimentari Autorizzazione del Tribunale di Milano n. 510 del 29-10-1983 Iscrizione al ROC n. 23531 dal 6 Maggio 2013
Tutti gli articoli pubblicati su Produzione & Igiene Alimenti sono redatti sotto la responsabilità degli Autori. La pubblicazione o la ristampa degli articoli deve essere autorizzata per iscritto dall’Editore. Ai sensi dell’art. 13 del Regolamento Europeo per la Protezione dei Dati Personali 679/2016 di seguito GDPR, i dati di tutti i lettori saranno trattati sia manualmente, sia con strumenti informatici e saranno utilizzati per l’invio di questa e di altre pubblicazioni e di materiale informativo e promozionale. Le modalità di trattamento saranno conformi a quanto previsto dal GDPR. I dati potranno essere comunicati a soggetti con i quali Quine Srl intrattiene rapporti contrattuali necessari per l’invio delle copie della rivista. Il titolare del trattamento dei dati è Quine Srl, Via Spadolini 7 - 20141, Milano, al quale il lettore si potrà rivolgere per chiedere l’aggiornamento, l’integrazione, la cancellazione e ogni altra operazione di cui all’art. 7 D.Lgs. 196/03.
Testata Associata


MASSIMO ARTORIGE GIUBILESI
Presidente Ordine dei Tecnologi Alimentari
Lombardia e Liguria
TRA PANICO E OPPORTUNITÀ
Cari colleghi Tecnologi Alimentari siamo sinceri: quanti di noi hanno già chiesto a ChatGPT di scrivere una procedura HACCP? (silenzio imbarazzato in platea!). Secondo un recente studio di McKinsey, il 63% dei professionisti
mercato globale dell’AI nel settore alimentare manager e innovatore
del settore alimentare ha già sperimentato strumenti di AI nel proprio lavoro quotidiano e il restante 37% probabilmente sta mentendo.
Dunque, siamo di fronte a una grande rivoluzione o siamo in panico perché temiamo che la tecnologia ci sovrasti? In qualsiasi modo la prendiamo, i numeri sono impressionanti: il mercato globale dell’AI nel settore alimentare, che nel 2020 valeva appena 5,3 miliar-
di di dollari, raggiungerà i 29,4 miliardi nel 2025, con una crescita media annuale del 45,7% che farebbe impallidire anche il lievito più attivo. Mentre leggiamo queste righe, probabilmente un algoritmo sta analizzando la shelf-life di un prodotto molto più velocemente di quanto abbiamo mai fatto con i nostri fidati Excel (ammettiamolo, spesso usiamo ancora Excel nella versione 2013!). Ma parliamoci chiaro: l’AI sta già rivoluzionando inesorabilmente il nostro settore. Nel 2023, NotCo – startup cilena valutata oltre 1,5 miliardi di dollari – ha fatto scalpore utilizzando la sua AI “Giuseppe” per sviluppare alternative vegetali che replicano il gusto della carne con una precisione del 95%. Un risultato che avrebbe richiesto anni di test sensoriali, migliaia di assaggiatori annoiati e tonnellate di caffè per tenerli svegli. La loro maionese vegana creata dall’AI, analizzando la struttura molecolare dell’originale, è già in vendita in Italia e molti consumatori non hanno notato la differenza (non
ditelo ai puristi della maionese). E sì, anche quegli assaggiatori (panel leader e giudici sensorialisti) stanno iniziando a preoccuparsi per il loro futuro. Inutile, dunque, raccontarcela diversamente: l’elefante è già nella stanza, o meglio i robot sono nelle cucine e nei laboratori. Lo conferma l’Osservatorio del Politecnico di Milano: il 78% delle aziende alimentari italiane prevede di incrementare gli investimenti in AI nei prossimi tre anni. E qui arriva la domanda che tutti ci facciamo durante le riunioni, ma che nessuno osa pronunciare ad alta voce: “Mi stanno per sostituire con un software?”. Stando con i piedi per terra, la risposta breve a questa domanda è: No. Quella lunga è: No, ma forse il TA 4.0, ovvero quel TA del futuro che sarà mezzo uomo e mezzo AI (ma con gusto!). Questa risposta ibrida è dovuta al fatto che già oggi l’AI può fare molte cose: analizzare dati, ottimizzare ricette, migliorare processi, ridurre scarti e sfridi e prevedere tendenze. Ma non può, ad esempio, gestire una crisi quando il cliente chiama alle 23:45 del venerdì sera oppure capire perché quel prodotto “tecnicamente perfetto” proprio non piace al mercato.
Nel 2023, solo il 15% delle decisioni critiche nel settore alimentare è stato completamente automatizzato. Il restante 85% richiede ancora quel mix unico di competenza tecnica, intuizione e capacità di gestire il panico che solo un Tecnologo Alimentare può offrire.
Secondo LinkedIn Industry Report 2024 le competenze più richieste per i Tecnologi Alimentari nel 2024 includono: Data Analysis (perché i numeri sono i nuovi ingredienti), Machine Learning basics (non significa imparare a riparare l’impastatrice) e Soft Skills (qualcuno dovrà pur spiegare ai robot cosa significa “q.b.”)
Nel 2024, mentre l’automazione avanza, il nostro ruolo diventa ancora più cruciale: noi TA siamo i traduttori tra il mondo dei bit e quello dei sapori, tra gli algoritmi e le emozioni che solo il cibo sa suscitare. L’AI nel settore alimentare è come il lievito madre: può fare meraviglie, ma ha bisogno di qualcuno che sappia come gestirla. E quel qualcuno siamo proprio noi, i Tecnologi Alimentari.
Dobbiamo però anche essere certi che, mentre leggeremo questo articolo, migliaia di sviluppatori stanno lavorando a nuovi algoritmi che potrebbero rendere obsolete le competenze che davamo per scontate. La domanda non è più “se” l’AI entrerà nel nostro lavoro, ma “quando” diventerà indispensabile come il nostro amato rifrattometro. E sì, lo so cosa stiamo pensando: “Ho già troppo da fare, non ho tempo per studiare anche l’AI”. Ma ricordate quando dicevamo la stessa cosa dell’HACCP, delle certificazioni, dei software gestionali o dei social media per promuovere i nostri servizi?
La verità scomoda è che nel 2025 un Tecnologo Alimentare che non capisce l’AI è come un cuoco che non sa accendere i fornelli. Possiamo anche essere brillanti nelle nostre competenze tradizionali, ma rischiamo di rimanere tagliati fuori dalle opportunità più interessanti (e redditizie) del settore. Ecco perché la formazione continua non è più un’opzione, ma è una questione di sopravvivenza professionale. E non parlo solo di seguire qualche webinar tanto per dire “ci sono stato”. Parlo di immergerci a capofitto nel mondo dell’AI con la stessa passione con cui studiavamo le fermentazioni all’università. Magari all’inizio ci sentiamo un po’ persi e goffi come quando facevamo i primi bilanci di massa o quando ci perdevamo nelle differenze tra pastorizzazione e sterilizzazione. L’importante è iniziare perché il tempo delle mezze misure è finito.
P.S. Ho chiesto all’AI di scrivere una battuta finale. Ha risposto: “Error 404: Humor not found”. Ecco perché il nostro lavoro è al sicuro. Per il momento…

“L’industria guarda alla professione del Tecnologo Alimentare con grande stima e anche grande interesse in quanto figura fondamentale nello sviluppo dei prodotti e dell’innovazione”, esordisce Paolo Mascarino, Presidente di Federalimentare, al convegno digitale AlimentiPiù.
Educare i consumatori a seguire diete sane e informarli del reale apporto nutrizionale di ciascun alimento
“L’industria alimentare ha chiuso il 2023 con un fatturato di 195 miliardi, ponendosi al primo posto delle manifatture in Italia. Risultati da record raggiunti anche nell’export con 53 miliardi; questo valore è raddoppiato nel decennio 2013-2023, un risultato che testimonia quanto l’industria alimentare italiana sia solida e competitiva, grazie anche a prodotti straordinari che vincono sui mercati
di tutto il mondo. L’industria alimentare, non considerando il settore primario, si posiziona al secondo posto per numero di imprese e numero di addetti, con circa 480.000 addetti che operano in 60.000 imprese. Il settore è costituito da migliaia di piccole e medie imprese, guidate da imprenditori che guardano al lungo periodo e resistono alle crisi. La caparbietà e il saper fare italiano sono la forza del nostro settore e permettono all’agroalimentare di continuare a crescere.
L’export ha continuato ad avere importanti sviluppi anche nel 2024, registrando nel primo semestre dell’anno scorso una crescita dell’8%, stimando un fatturato complessivo di 58 miliardi di euro. Questo straordinario risultato dell’export compensa la contrazione del fatturato nel mercato nazionale, dovuto all’inflazione e alla conseguente riduzione della capacità di acquisto.
L’industria alimentare ha obiettivi ambiziosi, tra cui quello di raggiungere i 100 miliardi di export, ma si scontra con alcune problematiche. Il nostro Paese, per esempio, è autosufficiente nella produzione delle materia
prime solo nella filiera del vino, dell’ortofrutta e nel settore del pollame; al contrario per il settore lattiero-caseario raggiungiamo un autosufficienza dell’81%, che scende però al 30% per il frumento tenero. Un forte limite allo sviluppo dell’export è, quindi, la reperibilità di materie prime sufficienti per permettere all’industria di trasformare queste materie prime in prodotti straordinari apprezzati in tutto il mondo. Come Federalimentare ci stiamo confrontando con le rappresentanze agricole e con i ministeri competenti per aumentare la capacità produttiva del settore primario. Sicuramente l’innovazione sarà fondamentale per tutelare da eventi climatici estremi, migliorare e incrementare le nostre produzioni nazionali. L’Italia sta spingendo molto a livello europeo per sperimentare le TEA, le tecniche di evoluzione assistita, che permettono di accelerare lo sviluppo delle coltivazioni, rendendole più robuste e più resistenti.
Per combattere l’obesità e le malattie non trasmissibili si vuole regolamentare in maniera molto severa il settore dell’alimentazione. L’obesità è un fenomeno crescente in tutto il mondo e si pensa di poterlo contrastare classificando gli alimenti in sani e non sani attraverso algoritmi matematici basati su somme e sottrazioni di nutrienti su 100 grammi di prodotto. Queste nuove classificazioni arbitrarie bollano in rosso prodotti come l’olio d’oliva e il Parmigiano Reggiano. La soluzione è, invece, educare i consumatori a seguire diete sane e informarli del reale apporto nutrizionale di ciascun alimento assunto nelle porzioni raccomandate dai nutrizionisti. Per questo motivo l’Italia si è battuta contro il NutriScore, trovando importanti alleanze negli altri paesi del Mediterraneo (Spagna e Grecia) e nei paesi dell’Est Europa (Romania, Repubblica Ceca, Ungheria e Polonia). Le ragioni dei paesi contrari sono state accolte anche da grandi aziende che hanno iniziato ad abbandonare il NutriScore precedentemente integrato nei loro packaging. A settembre 2025 si terrà presso l’ONU il vertice mondiale sulle malattie non trasmissibili, occasione in cui verrà presentato ai capi di Stato e di governo una proposta di policy da applicare in tutto il mondo per combattere l’obesità. Le istituzioni internazionali sono intenzionate a replicare anche nel nostro settore il successo ottenuto nel settore del fumo grazie a normative più stringenti, perché convinti che siano gli alimenti a provocare questa epidemia di obesità, il quale è il prerequisito per lo sviluppo di ulteriori problemi di salute e malattie come il diabete. Imporre, per esempio, etichette per il vino in cui si sostiene che il consumo di tale prodotto può provocare il cancro sarebbe un gravissimo danno al nostro settore vinicolo, dal momento che non esistono prove scientifiche evidenti della correlazione tra un consumo moderato di vino e l’insorgere della malattia.
Le sfide sono diverse: climatiche, fitosanitarie e regolamentatorie. Sono sfide importanti, ma il governo ci sostiene, così come i governi precedenti hanno sempre sostenuto questo settore in modo trasversale. Quando sono stato a Bruxelles, dove ho incontrato i nuovi europarlamentari italiani, abbiamo parlato delle opportunità e delle sfide del settore e ho trovato una sintonia assoluta su tutto l’arco costituzionale dei vari partiti rappresentati in Europa. Abbiamo la certezza di avere il sistema Paese che ci sostiene, sappiamo di avere professionisti in tutti i settori che ci aiutano a innovare, a produrre e a dare valore alla nostra industria con prodotti straordinari, so il contributo che danno i Tecnologi Alimenti alla nostra industria con la loro competenza, passione e inventiva che permettono di migliorare i nostri prodotti, quindi sono sicuro che tutti insieme riusciremo anche quest’anno a raggiungere risultati straordinari e a vincere le grandi sfide che ci attendono”.

BENEDETTA BOTTARI
Professore Associato
Microbiologia degli Alimenti
Università degli Studi di Parma
Si legge sul New York Times che gli esperti di previsioni prevedono per il 2025 un anno di scelte alimentari insolite. Le tendenze emergenti delineano quindi un panorama ricco di opportunità per produttori, distributori e consumatori. Ma quale sarà l’impatto di queste tendenze su produzione e igiene degli alimenti?
La produzione agricola d’oltreoceano sembra orientarsi verso prodotti più audaci. L’introduzione di frutta e verdura “designer”, come le barbabietole Badger Flame, apparenza pirotecnica e gusto di carote e miele, o le fragole Tropical Bliss, al sapore di frutti tropicali, dimostra un crescente interesse per la manipolazione genetica e lo sviluppo di semi che migliorano il sapore, la qualità nutrizionale e la sostenibilità. Questo approccio richiede un’attenzione particolare agli standard di igiene nella filiera produttiva per garantire la sicurezza alimentare, specialmente in un contesto di innovazioni così rapide. Lo stesso vale per la preparazione, il confezionamento e la distribuzione di prodotti da asporto, il cui consumo appare in ulteriore espansione, ispirato anche ai konbini giapponesi (negozietti di vicinato, aperti 24 ore al giorno, 7 giorni alla settimana, dove si vende un po’ di tutto e si preparano pasti caldi di qualità) che stanno prendendo sempre più piede anche in USA, ma strizzano l’occhio anche all’impegnatissimo, o forse pigro, consumatore del Bel Paese. Sfruttare questa tendenza al meglio, da parte dell’industria alimentare, rappresenta una grande sfida logistica, per garantire prodotti non solo gustosi ma anche sicuri dal punto di vista microbiologico.
Il desiderio di innovazione tocca anche il comparto bevande: caffè con sapori salati, infusi con ingredienti come topinambur, avocado e spezie esotiche, e bevande non alcoliche arricchite con psicoattivi come cannabis, kava o GABA. In questo caso le sfide sono di tipo regolatorio e di produzione. Tali nuove frontiere del gusto richiedono standard rigorosi per la gestione degli ingredienti, in particolare se attivi, la loro tracciabilità e la prevenzione di contaminazioni crociate e per assicurare la stabilità del prodotto nel tempo. A questo può contribuire anche il packaging che sta diventando parte integrante dell’esperienza alimentare, con soluzioni sempre più creative e sostenibili. L’uso di materiali riciclabili e innovativi non deve mai compromettere la sicurezza alimentare: un imballaggio accattivante, talvolta un’opera d’arte, deve garantire protezione contro contaminazioni microbiologiche e chimiche.
In conclusione, l’industria alimentare si trova di fronte a un’evoluzione senza precedenti, spinta dall’innovazione tecnologica, dall’esplorazione di nuovi sapori e dall’attenzione crescente verso la sostenibilità. L’innovazione deve andare di pari passo con un approccio rigoroso alla sicurezza e alla qualità. Produttori, distributori e fornitori di servizi alimentari hanno la responsabilità di cogliere queste opportunità con un’attenzione costante ai principi fondamentali di igiene e sostenibilità. Solo così sarà possibile costruire un futuro alimentare che risponda alle esigenze di consumatori sempre più informati e consapevoli.
Dal 3 all’8 maggio 2025 IFFA metterà al centro dell’attenzione i temi chiave del futuro dell’industria della carne e delle proteine. Con il motto “Rethinking Meat and Proteins”, la principale fiera settoriale internazionale offrirà una panoramica completa della catena del valore: dalla lavorazione e confezionamento agli ingredienti innovativi e alle ultime tendenze nel punto vendita. L’evento ha già registrato un’elevata adesione degli espositori e la conferma della partecipazione da parte dei leader di mercato. I temi centrali dell’edizione 2025 saranno: Raggiungere prestazioni di livello superiore, Creare valore dai dati, Mettere in atto la sostenibilità e Creare varietà di prodotti. Un nuovo layout dei padiglioni espositivi metterà in risalto l’ampia gamma di tecnologie innovative in mostra, rafforzando al tempo stesso la connessione tra le diverse fasi del processo produttivo. Importante novità dell’edizione 2025 sono gli IFFA Worlds: aree espositive tematiche che raggruppano le offerte dei diversi settori
World of Processing: soluzioni per la lavorazione sicura ed efficiente di carne e proteine.
World of Packaging: concetti innovativi per proteggere, conservare e presentare gli alimenti.
World of Ingredients: componenti essenziali per il sapore, la struttura e la qualità.
World of New Proteins: tecnologia, ingredienti e ricerca per tutti i tipi di alternative alla carne.
World of Skills and Sales: conoscenze e competenze per una lavorazione artigianale di alta qualità e una clientela soddisfatta.

merceologici, orientando il visitatore all’interno dei padiglioni della fiera.
Wolfgang Marzin, Presidente e CEO di Messe Frankfurt: “Le fiere riuniscono le industrie e IFFA 2025 ne sarà la prova lampante. La risposta degli espositori è stata impressionante e possiamo aspettarci numerose innovazioni per l’industria della carne e delle proteine. Gli espositori presenteranno soluzioni per aziende di ogni dimensione, per le diverse fonti di proteine e per ogni regione del mondo. Inoltre IFFA offre l’opportunità di dialogare e confrontarsi con i professionisti del settore, fare networking e acquisire nuove conoscenze”.
Il settore si riunisce a iffa per plasmare il futuro

Il commercio globale di macchinari per la lavorazione della carne è in crescita costante e ha raggiunto un nuovo record
di quasi 2,7 miliardi di euro nel 2023. La VDMA Food Processing and Packaging Machinery Association (NuV) prevede che la domanda globale di macchinari sicuri e ad alte prestazioni rimarrà stabile nel 2024. Tuttavia il settore deve affrontare sfide significative come le fluttuazioni dell’economia globale, l’aumento dei costi dell’energia, dei salari e delle materie prime e la carenza di manodopera qualificata che stanno mettendo le aziende sempre più sotto pressione.
Gli Italiani amano i prodotti surgelati: 9 su 10 li consumano abitualmente e, secondo un’indagine AstraRicerche per IIAS - Istituto Italiano Alimenti Surgelati [1], negli ultimi cinque anni, oltre 4 connazionali su 10 (39,3%) ne hanno aumentato il consumo, in particolare uomini (43%), giovani (Gen Z 50%, Millennials 45%) e famiglie con bambini (48%). Pratici, sicuri, anti-spreco e sempre a portata di mano, i surgelati sono cresciuti non solo in popolarità ma anche in termini di conoscenza e consapevolezza da parte dei consumatori, che li portano a tavola sempre più spesso, riconoscendone il valore.
Ma cosa gli italiani sanno o ancora ignorano di questi prodotti entrati ormai a pieno titolo nelle nostre abitudini alimentari quotidiane? IIAS e AstraRicerche hanno
indagato quanto sanno gli Italiani di alimenti surgelati e, a partire dai risultati, IIAS ha sviluppato un vademecum con alcune informazioni utili per scoprire “cosa c’è dietro a un surgelato”.
“Gli italiani hanno dimostrato un apprezzamento sempre crescente per gli alimenti surgelati, che scelgono e conoscono bene. Li prediligono per il gusto, come dimostra oltre la metà dei consumatori che dichiara di sceglierli per bontà, consistenza e percezione di freschezza [2]. E li acquistano anche per la loro convenienza economica, perché, se si considera il costo totale – tra prezzo del prodotto, tempi e costi di preparazione e valore del cibo sprecato – i surgelati consentono un risparmio notevole [3]”, spiega Giorgio Donegani, Presidente IIAS. “Ma, nonostante siano

sempre più presenti nei nostri freezer, ci sono ancora aspetti dei surgelati che i consumatori conoscono meno e su cui invece possiamo fare corretta informazione”.
La survey IIAS-AstraRicerche ci conferma che amiamo i surgelati e abbiamo imparato a conoscerli bene. Ad esempio, il 68,4% degli italiani sa che “congelato” e “surgelato” non sono sinonimi e il 64,5% del campione dimostra di sapere che non è possibile surgelare in casa, perché la surgelazione è una tecnica applicabile solo a livello industriale. Dall’altro lato, però, solo poco più di 3 italiani su 10 (31%) sanno che non è possibile acquistare prodotti surgelati sfusi, perché, per legge, devono sempre essere preconfezionati, al fine di garantire la maggiore sicurezza, o non sa che le verdure surgelate conservano per lungo tempo le stesse proprietà nutrizionali delle fresche (poco più di 1 consumatore su 2) o ancora ignora che i surgelati non contengono conservanti (59,9%), poiché la loro lunga durata è garantita esclusivamente dal freddo.
Sulle curiosità del comparto, i giovani sono i più preparati: il 45% degli italiani, soprattutto Gen Z e Millennials, conosce il trattamento di scottatura prima della surgelazione, che esalta il colore dei prodotti e si chiama blanching. Per quanto riguarda, invece, le giuste tecniche di scongelamento, solo 4 italiani su 10 sanno che il metodo più corretto consiste nel togliere il prodotto dal freezer e riporlo in frigorifero per qualche ora; mentre solo il 15% – in particolare i più giovani – sa che un prodotto surgelato, una volta scongelato può essere ricongelato a livello domestico, solo a patto che venga prima cotto. “Chi sceglie i surgelati sa tutto o quasi di loro. Oltre alle campagne di informazione, ad aiutare i consumatori a compiere scelte sempre più consapevoli ci pensano le etichette dei nostri prodotti. Circa 8 intervistati su 10 ci hanno detto di controllare scrupolosamente le indicazioni relative a
tempi e modalità di cottura dei prodotti surgelati. Anche questo è un chiaro segnale di quanto sia cresciuta l’attenzione verso la qualità e la sicurezza alimentare. Inoltre, l’86,4% di chi consulta le etichette conferma di impegnarsi a seguire fedelmente le indicazioni riportate, segnale di una maggiore consapevolezza verso gli alimenti che si mettono nel carrello”, continua Donegani.
[1] Survey AstraRicerche “Italiani e surgelati: #losapeteche?” (aprile 2024); campione di 1.000 italiani di età compresa tra i 18 e i 75 anni
[2] Blind Taste Test AstraRicerche (aprile 2024)
[3] Survey AstraRicerche sul “Value for money” dei surgelati (aprile 2024)
L’ultima indagine mensile sulle abitudini degli italiani nel fuori casa, il Consumer Pulse Report di CGA by NIQ, evidenzia le opportunità di crescita delle sempre più conosciute bevande Ready To Drink. In particolare, l’analisi pone l’attenzione sul potenziale dei RTD alcolici: il 26% dei consumatori dichiara di aver acquistato uno di questi prodotti negli ultimi tre mesi, mentre il 49% potrebbe considerare l’idea di consumarne uno in futuro.
La ricerca aiuta a valutare il comportamento dei consumatori e a identificare le aree di crescita del settore, che a novembre 2024 ha registrato un sostanziale equilibrio vs lo scorso anno con l’84% dei consumatori che ha dichiarato di essere uscito a mangiare e il 55% di essere uscito per un drink. In particolare la ricerca ha analizzato il segmento RTD, sempre più conosciuto e presente nell’Horeca. Infatti, più di un terzo dei consumatori (35%) afferma di aver notato un aumento dei drink pronti da bere negli ultimi 12 mesi, mentre solo il 3% ha registrato una diminuzione.
È interessante notare come quasi un terzo

(31%) dei consumatori consideri il prezzo il fattore principale per incoraggiarli a scegliere questa tipologia di bevande e, allo stesso tempo, quasi la stessa percentuale (32%) lo percepisca come ostacolo per la scelta di questi drink (troppo costosi).
In entrambi i casi, è importante capire il pubblico di riferimento, per poter studiare e applicare una strategia di prezzo che sia vincente rispetto alle categorie in competizione.
Tra gli incentivi che favoriscono l’acquisto
dei RTD si ritrovano per il 27% dei consumatori, la promessa di un drink diverso dalle proposte abituali, la varietà di gusti offerti (27%), la comodità (17%), la fiducia in uno specifico brand (17%) e l’influenza di amici e familiari (16%). Il 36% degli italiani sostiene invece che vorrebbe una maggiore varietà di prodotti RTD. Infine l’elevato contenuto di zuccheri e il gusto ritenuto troppo dolce sono, rispettivamente per il 27% e il 23%, motivi che ostacolano l’acquisto.
Il Centro Studi della federazione segnala che nei primi 10 mesi del 2024 cresce e si consolida l’accelerazione del settore.
Dopo il +6,6% registrato a consuntivo 2023, c’è quindi un ulteriore progresso che conferma l’alimentare al vertice delle voci manifatturiere più performanti del Paese.
Secondo l’elaborazione dati del Centro Studi di Federalimentare sulle statistiche diffuse dall’Istat, l’industria alimentare italiana ha registrato una quota export nel periodo di 47.411,5 milioni di euro, con una crescita tendenziale del +9,0%
su gennaio-ottobre 2023, superiore al +8,6% segnato sui nove mesi.
“Negli ultimi cinque anni (2019-2024) l’export di settore è cresciuto del +56,3%”, sottolinea il Centro Studi di Federalimentare. “Un tasso praticamente doppio rispetto al +28,3% registrato in parallelo dall’export complessivo del Paese. L’incidenza dell’export dell’alimentare all’interno di quello nazionale totale è salita dal 7,8% del 2019 al 9,2% del 2024”.
Il fenomeno si lega alle performance di molti mercati, ma in gran parte alla spinta specifica del mercato statunitense,
che ha segnato un +18,4% sui dieci mesi. Esso dovrebbe toccare perciò, a consuntivo 2024, una quota pari a 7,8 miliardi, ponendosi a ridosso della Germania, mercato estero leader da sempre dell’alimentare italiano. Fra i grandi mercati dell’industria alimentare, vanno ricordate anche le crescite a due cifre della Polonia (+18,7%), del Canada (+16,6%), del Giappone (+12,5%) e dell’Australia (+15,4%).
A queste performance, si affiancano le spinte dei mercati europei, della Spagna (+7,7%), del Regno Unito (+6,3%), della Germania (+6,6%) e della Francia (+4,4%).
La nuova edizione del Centro Informazione Birra (CIB) di AssoBirra accende i riflettori sul ruolo della birra nel trend del “soft pleasure”, indagando come la bionda più amata sia in grado di accompagnare anche i momenti di relax domestico e i piaceri quotidiani del periodo invernale
L’inverno è la stagione che celebra i piaceri semplici e autentici, le atmosfere intime e i momenti da vivere con lentezza. È un periodo che invita a riscoprire la bellezza dei piccoli gesti quotidiani, a creare rituali di comfort e convivialità, a vivere momenti dedicati al relax e alla riscoperta delle tradizioni. In questo contesto la birra si afferma come una bevanda capace di accompagnare questi momenti, diventando un lusso accessibile e un complemento per arricchire i piccoli piaceri quotidiani e le tavole delle festività. Grazie alla sua versatilità si adatta a ogni occasione, dal calore domestico ai brindisi natalizi, esaltando non solo i momenti di condivisione, ma anche la cucina italiana, confermandosi un elemento polivalente e trasversale anche per la stagione invernale.
Sono queste alcune delle evidenze emerse dall’ultima indagine condotta da BVA Doxa per il Centro Informazione Birra (CIB) di AssoBirra, la fotografia periodica sul mondo birrario italiano attraverso lo sguardo dei consumatori, dei principali player della filiera birraria e della stessa AssoBirra, che per questa edizione accende i riflettori sul ruolo della birra nel trend del “soft pleasure” durante la stagione invernale.


I soft pleasure: la riscoperta dei piccoli
L’inverno trasforma i gesti quotidiani degli italiani in veri e propri rituali di comfort e relax. La casa è il luogo preferito e il fulcro di queste esperienze per l’86% degli intervistati: attività come guardare la TV (70%), rilassarsi sul divano (65%) o concedersi una doccia calda (62%) sono tra le preferite per ritrovare sensazioni di rilassamento e serenità. La Gen Z si distingue per la capacità di ritagliarsi più frequentemente momenti dedicati ai soft pleasure, fino a 4 volte a settimana. Il contatto con la natura è un altro elemento apprezzato, con circa il 40% degli intervistati che dichiara di trovare piacere nelle passeggiate all’aperto o nei momenti contemplativi accanto al camino. Le generazioni si mostrano in sintonia anche sul valore della condivisione, con il 63% che vive questi momenti in compagnia del partner o di amici, in particolare i Millennials (68%), mentre quasi la metà degli intervistati preferisce dedicarsi a questi rituali in solitudine.
Come la birra arricchisce l’inverno degli italiani
La scelta di una bevanda per accompagnare i momenti di relax invernale è una costante per quasi tutti gli italiani, con il 90% degli intervistati che dichiara di consumare regolarmente bevande calde o fredde durante i propri soft pleasure. Tra le preferenze spiccano tisane (64%), cioccolata calda (63%) e tè (62%), ma tra le bevande moderatamente alcoliche la birra
si distingue come protagonista, scelta da circa la metà degli intervistati (48%), superando anche il vino (46%). Anche nel contesto invernale la birra si conferma dunque un alleato apprezzato per la sua capacità di esaltare ogni esperienza e in grado di ridefinire il concetto di bevanda per tutte le stagioni. Quasi 1 italiano su 3 (29%) trova la birra particolarmente appagante nei momenti di relax casalingo, anche grazie al suo basso tenore alcolico. Tra le generazioni, Millennials e Gen X (48% complessivamente) associano la birra a momenti di relax e convivialità. La Gen Z, invece, la interpreta in chiave più dinamica e ne apprezza la versatilità (39%), percependola come una bevanda ideale per arricchire attività creative come cucinare, decorare per le feste o organizzare serate di intrattenimento.
“La birra è un pilastro della tradizione alimentare italiana, in grado di adattarsi a ogni stagione e occasione,” dichiara Andrea Bagnolini, Direttore Generale di AssoBirra. “Se da un lato evoca momenti estivi di condivisione e leggerezza, i dati di quest’ultimo CIB dimostrano come sia altrettanto protagonista dell’inverno: dal relax in casa ai brindisi natalizi, fino agli abbinamenti raffinati delle tavole festive. Si conferma così


un alleato versatile, capace di esaltare l’autenticità della convivialità italiana. Questa edizione mette in luce un tema chiave: la destagio nalizzazione del consumo. La birra non è legata a un solo periodo dell’anno, ma si integra nei piaceri di ogni stagione, riflettendo la ricca cultura gastronomica del nostro Paese. Inoltre, il crescente interes se per il food pairing evidenzia consumatori sempre più consapevoli, che la vedono non solo come una bevanda, ma come un mezzo per esplorare sapori e creare connessioni autentiche. Questo ruolo unico la rende protagonista sia dei momenti più intimi che delle celebrazioni festive, valorizzando il piacere dello stare insieme tutto l’anno”.
Birra, inverno e food pairing

Accompagnare i piccoli piaceri invernali con il consumo di alimenti è una pratica diffusa e condivisa tra le generazioni. Millennials e Gen Z dimostrano una maggiore propensione a ritagliarsi momenti di piacere durante la settimana, rispettivamente con l’83% e l’80%.
In questo contesto, circa un terzo degli intervistati considera la birra un elemento fondamentale per arricchire l’esperienza dei soft pleasure, grazie alla sua capacità di esaltare i sapori e adattarsi a diversi abbinamenti. Tra i cibi più scelti dai consumatori per accompagnare la birra emergono i salumi (51%) insieme con le focacce (51%), seguite da tartine o bruschette (47%) e formaggi stagionati o freschi (41%).
Questi alimenti, associati ai momenti di relax e condivisione, trovano nella birra un complemento capace di arricchire ogni occasione culinaria, grazie alla sua versatilità e al suo carattere conviviale.
“La cucina italiana, con la sua autenticità e raffinatezza, trova nella birra un elemento chiave, capace di arricchire ogni portata e dialogare con i sapori senza mai sovrastarli,” spiega Rocco Pozzulo, Presidente della Federazione Italiana Cuochi. “Durante le festività natalizie, la birra esalta dessert come il panettone e il cioccolato fondente, ma può anche diventare protagonista in cucina, ad esempio nelle ganache o in preparazioni salate. Penso agli abbinamenti con frutta secca tostata, cioccolato fondente o dolci tipici natalizi, che si sposano perfettamente con birre chiare o ambrate, ideali per bilanciare la ricchezza dei dessert. Un dessert che amo preparare combina birra bock, nocciole del Piemonte e tartufo bianchetto per un’esplosione di gusto. La birra incarna perfettamente il concetto di piacere lento e genuino, valorizzando la nostra tradizione gastronomica e creando rituali autentici e ricchi di sapore”.
Prendere le decisioni giuste – questa è la cosa più importante per ogni azienda alimentare. Report dettagliati, dati attuali dalla produzione, andamento degli ordini: il CSB-System vi fornisce esattamente questa trasparenza, semplicemente premendo un tasto. Così anche in tempi incerti potrete prendere decisioni certe.
Per saperne di più sulle nostre soluzioni per il settore alimentare: www.csb.com

Diletta Gaggia

LE TECNOLOGIE DI FINE LINEA RAPPRESENTANO IL 9,3% DEL MERCATO GLOBALE DEI MACCHINARI PER L’IMBALLAGGIO. UN SETTORE CHE RAGGIUNGERÀ I 5,6 MILIARDI DI EURO ENTRO IL 2027
Il settore delle tecnologie di imballaggio di fine linea sta vivendo una crescita significativa tra il 2023 e il 2027, raggiungendo un valore complessivo di 4,9 miliardi di euro nel 2023. È quanto emerge dall’Ipack-Ima Monitor pubblicato a dicembre 2024. Le prospettive indicano una crescita media annua del +3,2% (CAGR 2023-2027), un tasso che supera la crescita globale dei macchinari per l’imballaggio, stimata al +3,0%. Questo andamento positivo porterà il settore a un valore di 5,6 miliardi di euro entro il 2027.
Le tecnologie di fine linea rappresentano il 9,3% del mercato globale dei macchinari per l’imballaggio. La distribuzione delle quote mostra una forte concentrazione nei settori food&beverage, che insieme rappresentano il 60,9% del totale. Beverage rimane il settore leader con una quota del 31% e un valore di 1.524 milioni di euro nel 2023. Segue food, che rappresenta il 28,9% del totale, con un valore di 1.469 milioni di euro. Gli altri settori detengono il 18% delle quote, con un valore totale di 892 milioni di euro. Il settore farmaceutico rappresenta il 9,2% del totale, ovvero 451 milioni di euro,
mentre i settori chimico e cosmetico si attestano rispettivamente al 6,8% (331 milioni di euro) e al 5,2% (256 milioni di euro).
Analizzando le prospettive di crescita per il periodo 2023-2027, emergono dinamiche interessanti che invertono la classifica dei settori leader. Gli altri settori (tabacco, tissue, etc.) mostrano un incremento medio annuo del +4,1%, superando la media complessiva del settore End of Line. Anche il settore cosmetico mostra uno svilup-
po significativo, con una crescita prevista del +3,5% annuo. Il settore food rimane in linea con la media del settore, con un tasso del +3,2% annuo. Il beverage, pur rimanendo centrale, dovrebbe crescere a un tasso leggermente inferiore del +2,9% annuo. Chiudono la classifica il settore farmaceutico e quello chimico, entrambi con un CAGR del +2,6%.
Il settore End of Line Packaging Technologies conferma quindi una costante evoluzione, guidata dall’innovazione e dalla crescente domanda nei settori tradizionali,

con un significativo impulso proveniente dai mercati emergenti. Le prospettive indicano opportunità strategiche non solo nei settori più consolidati, ma anche in quelli meno tradizionali, offrendo nuove sfide all’intera filiera industriale.
Il mercato dei macchinari per l’imballaggio di fine linea mostra una netta concentrazione geografica, con Asia, Unione Europea e Nord America insieme che rappresentano quasi l’86% dell’intero valore d’uso. L’Asia è il leader indiscusso, rappresentando il 33,7% delle tecnologie utilizzate, con un valore complessivo di 1.656,9 milioni di euro. Seguono l’Unione Europea, che assorbe il 26,9% del mercato (1.325,7 milioni di euro), e il Nord America, al terzo posto con una quota del 25,3% e un va-

lore di 1.242,6 milioni di euro. Le restanti regioni si dividono la fetta residua del 14,1%. Tra queste, l’extra-UE si classifica al quarto posto con il 5% del totale e un valore di 245,4 milioni di euro. Poco dietro segue l’America Latina, che rappresenta il 4,9% del mercato (242,5 milioni di euro). Subito dietro ci sono Africa e Oceania, che insieme coprono solo il 4,2% del valore totale, ovvero 207,5 milioni di euro. Si tratta di una fotografia chiara di un settore in cui il peso delle grandi economie rimane predominante, ma che offre anche opportunità di crescita per le aree meno rappresentate.

Nel 2023, il fatturato italiano relativo alla produzione di End of Line Packaging Technologies ha raggiunto un valore di 1.310,1 milioni di euro, registrando una crescita del +3,3% rispetto al 2022. Nello stesso periodo, la Germania ha prodotto un valore di 812,4 milioni di euro, con un incremento dell’8,0% rispetto all’anno precedente. Sebbene l’Italia superi la Germania nel valore totale della produzione, quest’ultima mostra una performance di crescita più forte rispetto all’anno precedente. Osservando la composizione della produzione italiana, emerge che il segmento beverage contribuisce maggiormente al fatturato con una quota del 34,8%, per un valore di 455,3 milioni di euro nel 2023. Seguono gli altri settori, che rappresentano il 24% del totale, con un valore di 314,8 milioni di euro. Al terzo posto si colloca il settore alimentare, con una quota del 23% e vendite pari a 302,0 milioni di euro. Nel complesso, food&beverage rappresenta il 57,8% della produzione totale, generando un valore complessivo di 757,3 milioni di euro nel 2023, più della metà del settore.

DOI: 10.1016/j.crfs.2024.100707
Approcci TaqMan® e HRM per la genotipizzazione SNP nella tracciabilità genetica di mosti e vini
TaqMan® and HRM approaches for SNP genotyping in genetic traceability of musts and wines. Current Research in Food Science, Volume 8, 2024
A. Moine, P. Boccacci, C. De Paolis, L. Rolle, G. Gambino
La lotta alle frodi nel settore vitivinicolo richiede continui miglioramenti e validazioni delle nuove tecnologie applicabili a mosti e vini. A partire dai dati pubblicati dall’array Vitis18kSNP, sono stati identificati una serie di nuovi marcatori specifici di polimorfismo a singolo nucleotide (SNP) per alcune importanti cultivar dell’Italia nord-occidentale, come Barbera, Dolcetto e Arneis (Vitis vinifera L.), utilizzate nella produzione di vini di alta qualità a Denominazione di Origine Protetta. Una coppia di nuovi marcatori SNP per ciascuna varietà di uva è stata selezionata e convalida-
ta utilizzando due tecniche PCR in tempo reale: test di genotipizzazione TaqMan® e analisi di fusione ad alta risoluzione (HRM). Il test TaqMan® ha dimostrato di essere più affidabile e ripetibile dell’analisi HRM perché, nonostante sia una tecnica economica e versatile per la rilevazione di diversi tipi di mutazioni genomiche (SNP, inserzioni o delezioni), l’HRM ha mostrato limitazioni in presenza di scarso DNA di qualità estratto da mosti e vini. I test TaqMan® hanno identificato con successo Barbera, Dolcetto e Arneis nei rispettivi mosti e vini sperimentali, e con buona efficienza nei vini commerciali. Sono state osservate differenze marcate tra i genotipi, l’identificazione varietale nei mosti/ vini a base Dolcetto è stata più efficiente di quella nei vini a base Arneis. Pertanto, il test TaqMan® ha un potenziale considerevole per l’identificazione varietale nei vini e la procedura descritta nel presente lavoro può essere facilmente adattata a tutti i vini con un’adeguata configurazione dei metodi di estrazione del DNA che dovrebbero essere adattati a vini diversi.


DOI: 10.1016/j.cej.2023.148474
Sensore colorimetrico a microaghi che utilizza un algoritmo di deep learning per il monitoraggio della freschezza della carne
Colorimetric microneedle sensor using deep learning algorithm for meat freshness monitoring. Chemical Engineering Journal, Volume 481, 1 febbraio 2024
J. Wang, L. Xia, H. Liu, C. Zhao, S. Ming, J. Wu
Attualmente, i metodi per determinare la freschezza della carne richiedono molto tempo, sono scomodi o richiedono elevati requisiti di specialità. I ricercatori hanno proposto un sensore colorimetrico a microaghi (CMS) utilizzando un algoritmo di deep learning algoritmo per il monitoraggio visualizzato della freschezza della carne. Il CMS è stato ottenuto stampando idrogel commestibili contenenti antociani sensibili al pH, che cambiano colore a causa del cambiamento strutturale degli antociani in risposta al pH. Quando attaccato alla carne, il CMS è in grado di penetrarla ed estrarre i fluidi tissutali mediante azione capillare. Con il deterioramento della carne, il pH del fluido tissutale aumenta gradualmente,

portando a un cambiamento nel CMS dal rosa al viola e infine al blu scuro. Pertanto, in base alle variazioni dei colori CMS, è stato ottenuto il rilevamento in situ e visualizzato della freschezza della carne. Inoltre, è stato applicato un algoritmo di deep learning da integrare con il CMS per formare un’applicazione per smartphone (app), consentendo un rilevamento della freschezza più comodo e accurato. Sono state raccolte immagini di CMS allegate alla carne con diversa freschezza per formare una fonte di training come input della rete neurale convoluzionale (CNN). Attraverso le caratteristiche cromatiche contorte del CMS, è stata infine classificata la freschezza della carne come “fresca”, “meno fresca” e “guastata”. Con l’incorporazione della CNN, l’app ha consentito agli utenti di identificare la freschezza della carne dalle foto archiviate o dalle immagini in tempo reale di carni etichettate con CMS in modo rapido, accurato, portatile e universale. Questa strategia di rilevamento visualizzato del CMS combinata con un’app integrata con algoritmo ha un potenziale promettente per ampie applicazioni come la sicurezza alimentare, il monitoraggio della salute e la protezione ambientale.
DOI: 10.1016/j.foodcont.2024.110359
Sistemi di confezionamento intelligenti per il monitoraggio della qualità e della sicurezza dei prodotti a base di carne: dalla scala di laboratorio all’industrializzazione
Intelligent packaging systems for the quality and safety monitoring of meat products: From lab scale to industrialization. Food Control, Volume 160, giugno 2024
M. Alizadeh Sani, W. Zhang, A. Abedini, A. Khezerlou, N. Shariatifar, E. Assadpour, F. Zhang, S. Mahdi Jafari
Il consumo di carne è aumentato notevolmente negli ultimi 50 anni, con un mercato mondiale di carne fresca e lavorata che si prevede raggiungerà una dimensione di 292,92 milioni di tonnellate entro il 2027. Tuttavia, il deterioramento della carne e dei prodotti a base di carne possono causare perdite economiche per i produttori e rischi per la salute dei consumatori. Per risolvere questo problema, è stato sviluppato materiale di imballaggio intelligente con indicatori e sensori, come codici a barre ed etichette a radiofrequenza, per garantire controllo di qualità e sicurezza. Questi progressi hanno rivoluzionato il settore degli imballaggi riducendo le perdite e prolungando la durata di conservazione. Inoltre, i sistemi di imballaggio intelligenti (IPS) forniscono informazioni in tempo reale ai consumatori sullo stato del prodotto. Ciò ha migliorato la qualità
generale e la sicurezza degli alimenti confezionati deperibili come la carne. Tuttavia, la maggior parte degli studi sono condotti su scala di laboratorio e ci sono molti problemi da risolvere oltre agli ostacoli legati ai costi per applicarli a livello industriale. La transizione dalla scala di laboratorio all’industrializzazione degli IPS comporta sfide e limitazioni. Una delle sfide principali è aumentare la produzione mantenendo la funzionalità e l’affidabilità degli IPS. Ciò richiede investimenti significativi in attrezzature e processi. Inoltre, garantire la compatibilità degli IPS con i processi e gli standard industriali esistenti può rappresentare un ostacolo. Un’altra sfida è la necessità di test e convalide approfonditi per soddisfare i requisiti normativi e garantire la sicurezza e l’efficacia degli IPS. Superare queste sfide è fondamentale per integrare con successo gli IPS nei processi di produzione industriale. Questa revisione si concentra sulla ricerca scientifica continua e sullo sviluppo delle tecnologie più recenti, dalla scala di laboratorio all’industrializzazione, attraverso un approccio per monitorare i cambiamenti fisici, chimici e microbici nei prodotti a base di carne confezionati in ambienti industriali utilizzando imballaggi multifunzionali intelligenti. Questa revisione fornisce inoltre una panoramica aggiornata della correlazione tra scala di produzione e consumo, deterioramento del prodotto e parametri sperimentali come pH, azoto basico volatile totale (TVB-N) e carica microbica.

DOI: 10.1016/j.ijgfs.2024.100883
Il Paese d’origine come induttore di pregiudizi nei giudizi sul vino degli esperti - Un esperimento sensoriale in una fiera mondiale del vino
Country-of-Origin as bias inducer in experts’ wine judgments - A sensory experiment in a world wine fair. International Journal of Gastronomy and Food Science, Volume 35, marzo 2024
N. Depetris Chauvin, D. Valentin, JH. Behrens, H. Rodrigues
L’obiettivo principale del presente studio è valutare se l’origine del vino induce pregiudizi impliciti nei giudizi degli esperti. A ventidue commercianti di vino provenienti da 10 paesi diversi è stato chiesto di valutare il gradimento e di fornire una descrizione sensoriale di otto vini Pinot Nero provenienti da quattro paesi diversi (Argentina, Brasile, Francia e Svizzera) in condizioni sia cieche che informate alla “ProWein International Wine and Spirits Fair” edizione 2018 a Dusseldorf, Germania. Nella condizione informata, ai partecipanti è stato fornito il paese di origine (COO) del vino. Una volta reso noto il COO, le valutazioni di simpatia dei vini provenienti da Argentina e Brasile sono diminuite. Il COO ha anche dedotto errori nel modo in cui i valutatori hanno descritto/giudicato i vini nelle tre condizioni di valutazione: visiva, ortonasale e gustativa. I vini brasiliani e argentini sono spesso descritti utilizzando descrittori edonistici negativi in condizioni informate. È stata osservata anche la tendenza opposta. Quando i valutatori erano a conoscenza dell’origine dei vini, spesso descrivevano i vini francesi e svizzeri aggiungendo descrittori sensoriali positivi. Questi risultati sono utili per i consumatori di vino, i produttori, l’industria della gastronomia e per i politici che prendono decisioni sulle leggi.

DOI: 10.1016/j.cofs.2024.101127
Film con attività antimicrobica per prodotti a base di carne
Films with antimicrobial activity for meat products. Current Opinion in Food Science, 19 gennaio 2024
N. Walayat, PC. Bastianello Campagnol, W. Zhang, Z. Su, JM. Lorenzo
In questo articolo vengono discussi i problemi relativi alla carne e ai prodotti a base di carne, utilizzando le pellicole antimicrobiche come possibile soluzione. Gli autori hanno discusso i diversi tipi di pellicole antimicrobiche studiati negli ultimi anni con le sfide e i miglioramenti apportati da diversi ricercato -
ri. Dal punto di vista degli autori, l’uso di pellicole antimicrobiche estratte da fonti naturali è una strategia promettente per ridurre al minimo la crescita di microrganismi nella carne e negli articoli a base di carne senza cambiamenti fisico-chimici e sensoriali che possano promuovere l’accettabilità del consumatore e un approccio economicamente efficiente. Gli autori hanno suggerito che è necessaria una maggiore ricerca sulla standardizzazione e sui parametri tecnici nello sviluppo di pellicole antimicrobiche efficaci e a basso costo. Inoltre, secondo l’opinione degli autori, è possibile eseguire studi di citotossicità su pellicole antimicrobiche per la sicurezza dei consumatori.
















Diletta Gaggia
I CHALLENGE TEST SONO STRUMENTI ESTREMAMENTE VANTAGGIOSI PER VALUTARE LA SICUREZZA
ALIMENTARE E PER DEFINIRE LA SHELF LIFE, I PARAMETRI DI PROCESSO E DI PRODOTTO
Il challenge test nasce come strumento per dare un contributo alla valutazione della sicurezza degli alimenti, ma è applicato oggi anche per tutti gli aspetti legati alla qualità microbiologica.
Nel 2022 si sono registrate più di 5.700 epidemie di origine alimentare e hanno registrato rispetto all’anno precedente un incremento significativo (+40%).
A queste epidemie sono stati associati oltre 48.000 casi di malattia, con un numero molto elevato di ospedalizzazioni, riferite soprattutto a casi di salmonellosi. Sono stati registrati 64 decessi, di questi la metà è da imputarsi alla Listeria monocytogenes . Oltre all’effetto diretto che ha sul consumatore, il pericolo microbiologico ha ricadute più ampie
anche sul contesto sociale, le persone tendono a non acquistare più i prodotti coinvolti in episodi noti, e industriale con conseguente perdita del fatturato. “Fortunatamente, all’interno dell’Unione Europea beneficiamo di ottimi strumenti che permettono di tenere sotto controllo il rischio associato alla presenza di questi microrganismi patogeni nel corso della filiera produttiva”, spiega Valentina Bernini , docente presso il Dipartimento di Scienze degli Alimenti e del Farmaco dell’Università di Parma.
A COSA SERVONO I CHALLENGE TEST?
I challenge test sono degli strumenti scientifici che permettono di determinare la capacità di uno o più microrga -
Nel 2022 si sono registrate più di 5.700
epidemie di origine alimentare
VALENTINA BERNINI
Docente presso il Dipartimento di Scienze degli Alimenti e del Farmaco dell’Università di Parma. Valentina Bernini si occupa di microbiologia alimentare anche in qualità di ricercatrice, seguendo due ambiti di ricerca. Il primo legato all’utilizzo di batteri lattici per la fermentazione, non solo per ottenere nuovi prodotti alimentari, ma anche per la valorizzazione di sottoprodotti dell’industria di trasformazione; mentre il secondo ambito di ricerca è più inerente agli aspetti di sicurezza alimentare, quindi tutto ciò che concerne l’identificazione e la caratterizzazione di patogeni che hanno un ruolo nella contaminazione degli alimenti, in questo ambito si occupa anche dello sviluppo e dell’allestimento di challenge test microbiologici.

nismi di crescere e svilupparsi in un alimento, ma anche di verificare l’efficacia di un step di processo nell’inibizione o nella riduzione, al di sotto di quella che è considerata la soglia di pericolo per i consumatori, di microorganismi che possono eventualmente entrare all’interno del processo di produzione. Interessando sia lo sviluppo in un alimento che la valutazione degli step di processo si differenziano in due categorie. Il challenge test di prodotto è una simulazione di contaminazione eseguita in sito, quindi in condizioni reali, che avviene sul prodotto solo al termine del processo produttivo; in questo caso non è importante la storia produttiva che ha permesso di ottenere quel prodotto, ma valutare cosa potrebbe accadere nella shelf life di quel prodotto nel caso in cui si riscontrasse una contaminazione all’interno del processo produttivo.
Nel caso del challenge test di processo viene analizzato il processo di trasformazione, perché, molto spesso, in questa simulazione si procede con la contaminazione della materia prima,
si va a condurre una trasformazione in quelle che sono le effettive correzioni operative e si va a verificare se particolari step di processo abbiano un effetto significativo nel controllo dei microrganismi.
CORRETTA PROGETTAZIONE
DELLA SPERIMENTAZIONE
Prima di progettare un challenge test, è necessario individuare i target che sono interessati nel particolare studio, ovvero quei microrganismi che possono essere riscontrati come contaminanti di quel prodotto o di quel processo e che sono anche collegati a casi epidemio -
logici. Dopo aver identificato la specie di interesse è importante selezionare correttamente i microrganismi, quindi nello specifico i ceppi che vengono utilizzati per questa contaminazione artificiale. Si tratta dunque di dover identificare delle miscele di microrganismi appartenenti alla specie target, in quanto l’utilizzo di un singolo ceppo potrebbe non essere rappresentativo del comportamento della specie in quel prodotto o nel corso di quel processo, perché all’interno delle specie esistono comunque delle biodiversità. In conclusione l’utilizzo della miscela permette di ottenere delle risposte che si possono effettivamente ricondurre alla specie stessa ed elimina il rischio di ottenere degli scenari dettati da peculiari caratteristiche del singolo biotipo. Fondamentale è anche la scelta della modalità di inoculo. Il challenge test è una simulazione di contaminazione in condizioni reali quindi il monitoraggio del comportamento del microrganismo deve avvenire nelle condizioni in cui il consumatore, ad esempio, conserva il prodotto, quindi non bisogna nella fase di contaminazione andare a denaturare quella che è la struttura del prodotto per non andare a comprometterne da un punto di vista chimico-fisico le caratteristiche.
È necessario poi stabilire le condizioni di conservazione, identificare in modo preciso quelle che sono le fasi del pro -
UNI EN ISO 20976-1:2019
Microbiologia della catena alimentare- Requisiti e linee guida per condurre “Challenge tests” in alimenti e mangimiParte 1: “challenge tests” per lo studio del potenziale di crescita, lag time e il tasso di massima crescita.
UNI EN ISO 20976-2:2022
Microbiologia della catena alimentare - Requisiti e linee guida per condurre “Challenge tests” in alimenti e mangimi - Parte 2: “challenge tests” per lo studio del potenziale di inattivazione e dei parametri cinetici.

cesso o i punti degli impianti che vogliono essere monitorati e stabilire il piano di campionamento prima di iniziare la sperimentazione, perché la contaminazione del lotto soggetto ad analisi deve avvenire nello stesso momento.
SPERIMENTAZIONE SU LISTERIA MONOCYTOGENES
La notifica da parte del sistema di allerta RASFF di alcuni casi relativi al ritrovamento di Listeria monocytogenes in alcune mozzarelle, ha portato allo sviluppo di challenge test che andassero a focalizzarsi sulla capacità del microrganismo, una volta presente, ad esempio, nell’acqua di rassodamento utilizzata nel processo di produzione di aderire sulla superficie del prodotto e quindi analizzare anche il fatto che potesse eventualmente essere poi rilasciato nel contatto con altri liquidi che intervengono nelle fasi di processo.
A seguito di contaminazione dell’acqua di rassodamento, l’immersione di una mozzarella non contaminata, dopo un certo tempo di contatto sia del liquido dell’acqua di rassodamento che della mozzarella e successive operazioni, ha permesso, ad esempio, di stabilire come in poche ore già avvenga l’adesione e
nelle successive fasi di lavorazione parte del microrganismo rimane adeso e parte viene rilasciato nei liquidi. Questo
può, quindi, creare delle cross-contaminazioni tra anche i liquidi coinvolti nel processo che magari inizialmente non risultano contaminati, perché la contaminazione deriva da passaggi successivi. Un altro esempio legato sempre al prodotto, che analizza però un’operazione: il taglio delle forme formaggio gorgonzola. In questo caso il challenge test ha predisposto la contaminazione superficiale di intere forme di formaggio e poi la simulazione di operazioni di taglio. L’esperimento ha determinato delle percentuali di contaminazione della pasta, ovvero la parte edibile del formaggio. È possibile ridurre questo trascinamento controllando la contaminazione della crosta, il challenge test ha confermato l’importanza delle operazioni di manipolazione di questi prodotti.
Le norme comunitarie di riferimento disciplinano la modalità di produzione dei prodotti biologici e hanno un impatto indiretto in riferimento al good safety management. Tuttavia presenta delle lacune in merito alla gestione del pest management, perché non esplicita le tecniche e le modalità di gestione dei contaminanti nel settore dell’agricoltura biologica. “Partendo da questa consapevolezza”, illustra Mariano Serratore, Direttore Tecnico di ICEA che si occupa di tutti gli schemi di certificazione, “abbiamo strutturato, in collaborazione con ANID, uno standard di certificazione che va a entrare nel merito della gestione del pest management nelle aziende biologiche, in particolare lo standard definisce le modalità di gestione di certificazione del bio-pest management”. Questo standard si appoggia sia alla normativa volontaria sia alla normativa cogente, in particolare su un documento
tecnico redatto da un’apposita commissione strutturata comprendendo diversi stakeholder, pubblici e privati, e gestita direttamente da ANID.
Quali sono i requisiti basi per poter avviare questo standard di certificazione?
§ Politica aziendale orientata all’adozione di metodi e tecniche biologiche e sostenibili.
§ Formazione del personale sugli aspetti di Pest Management.
§ Analisi del rischio per ogni sito.
§ Monitoraggio e audit interni.
Partendo dal presupposto che un prodotto biologico è già molto qualificato, l’adesione a questo standard, anche nelle tecniche e nei processi aderenti al biopest management, contribuisce a creare un ulteriore valore aggiunto all’azienda stessa oltre che al prodotto finale.

Con l’adozione della digitalizzazione, le aziende possono semplificare e rendere più efficienti i processi di monitoraggio e controllo. MoreFromFood, una piattaforma sviluppata da Dotcom, è un esempio concreto di come la tecnologia possa trasformare la gestione della sicurezza alimentare, portando vantaggi nella gestione delle non conformità, nella tracciabilità e nella preparazione alle ispezioni.
Con MoreFromFood, le aziende possono centralizzare tutte le informazioni sulla sicurezza alimentare in un’unica piattaforma, facilitando l’accesso e la condivisione dei dati con vari stakeholders, dal management agli ispettori, fino ai clienti. La piattaforma permette di replicare i processi manuali con funzionalità avanzate, impossibili con il formato cartaceo. Un esempio è la gestione automatica delle non conformità: quando viene rilevato un parametro fuori norma (come temperatura o pH), il sistema invia un avviso immediato e avvia il processo di gestione, che include azioni correttive e la registrazione della risoluzione. Questo consente di reagire rapidamente,
evitando che piccoli problemi diventino gravi. La piattaforma digitale offre una gestione tempestiva e documentata rispetto ai sistemi cartacei, che possono essere lenti e imprecisi.
La preparazione agli audit e alle ispezioni è una delle principali preoccupazioni delle aziende alimentari. Con MoreFromFood, la preparazione diventa semplice e rapida. Le aziende possono accedere a tutti i dati e report necessari per dimostrare la conformità agli standard di sicurezza alimentare con pochi clic. I dati digitali riducono al minimo il rischio di errori e permettono di rispondere rapidamente alle richieste delle autorità. La gestione dei controlli interni, come la manutenzione delle strutture e l’igiene, è facilitata dalla piattaforma, che consente di documentare in tempo reale le ispezioni. Inoltre, la piattaforma si integra facilmente con altri sistemi aziendali, come gli ERP, permettendo di monitorare la tracciabilità dal ricevimento delle materie prime fino alla produzione.
Con MoreFromFood, tutte le informazioni sono centralizzate e facilmente ac-

cessibili, permettendo di generare report dettagliati sulle attività, sulle non conformità e sulle azioni correttive. Questo garantisce una gestione chiara e affidabile della sicurezza alimentare, aumentando la fiducia dei clienti e delle autorità.
Infine, MoreFromFood offre funzionalità di analisi dei dati. Sebbene la piattaforma non sia pensata per analisi complesse, si integra facilmente con strumenti come Power BI, permettendo di ottenere report dettagliati e visualizzare i trend delle attività.
In conclusione, MoreFromFood rappresenta una soluzione potente per la gestione della sicurezza alimentare. La digitalizzazione dei processi, la gestione automatica delle non conformità, la preparazione alle ispezioni e la centralizzazione dei dati consentono alle aziende di rispondere rapidamente alle sfide quotidiane e migliorare la qualità e la sicurezza dei loro prodotti.

Elena Consonni Giornalista esperta in scienze e tecnologie alimentari
NEGLI ULTIMI ANNI SI SONO RESI POSSIBILI NUOVI METODI DI INDAGINE PIÙ PERFORMANTI, SEBBENE ANCORA MOLTO COSTOSI E DI NON FACILE INTERPRETAZIONE, MA DESTINATI AD AFFERMARSI IN UN FUTURO PROSSIMO
La nuova frontiera dell’analisi degli alimenti è rappresentata dalle tecniche omiche. Si tratta di metodi molto evoluti, che prevedono la raccolta e l’analisi statistica di un gran numero di dati nello stesso intervallo di tempo, per descrivere nel dettaglio un sistema biologico.
“Con l’espressione tecniche omiche”, spiega Luigi Lucini, docente di Chimica agraria alla Facoltà di Scienze Agrarie, Alimentari e Ambientali dell’Università Cattolica, “intendiamo degli approcci analitici che vanno a caratterizzare un’intera classe di molecole. Per esempio, la genomica che è la prima delle tecniche omiche a essere adottata, caratterizza l’intero genoma, cioè tutti i geni di un organismo. Sono arrivate poi la trascrittomica, che identifica quali geni sono trascritti, la proteomica,
quando questi geni sono copiati e tradotti in proteine, e la metabolomica che descrive i metaboliti, cioè i composti chimici presenti all’interno di una cellula all’interno di un tessuto e anche in un alimento”. Questi approcci si sono resi possibili negli ultimi anni grazie all’evoluzione delle tecnologie di analisi, cioè alla disponibilità di strumenti d’analisi sempre più performanti. “Le tecniche che permettono di effettuare queste analisi”, sottolinea, “sono principalmente la spettrometria di massa e la risonanza magnetica nucleare. Si tratta però di strumenti molto evoluti, rispetto a quelli classici, che permettono di individuare 20 o 30 composti chimici in una matrice. Adesso si possono misurare 7.000-10.000 composti diversi, a seconda dipende dalla tecnica adottata, con una sola analisi”.


UN APPROCCIO NUOVO
Ma al di là delle possibilità offerte dalle innovazioni in ambito analitico, l’applicazione delle tecniche omiche in ambito alimentare prevede un cambio di mentalità. “Alla mia generazione,” racconta, “è stato insegnato che il metodo scientifico prevede un’ipotesi, che va verificata tramite un esperimento scientifico. Le scienze omiche sono un cambio di prospettiva: nel caso di un sistema molto complesso è molto difficile formulare un’ipotesi specifica precisa, allora il lavoro viene definito hypotesis free. Si lavora in maniera non mirata, cercando di caratterizzare completamente il sistema, che può essere appunto la cellula, l’organo, il tessuto o l’alimento, come nella mia attività”.
Una delle possibili applicazioni delle tecniche omiche in ambito alimentare è l’identificazione di frodi. “Per esempio,”
racconta Lucini, “se dovessi usare le tecniche omiche per individuare se un olio etichettato DOP è invece proveniente da un’altra zona, dovrei analizzare diverse annate di quell’olio senza cercare nulla in particolare, e trattare i risultati ottenuti con tecniche di statistica evolute per evidenziare l’impronta chimica di quell’olio, al di là della singola annata. Questa impronta chimica diventa il marcatore che identifica l’olio proveniente da quella zona. Se in un campione di olio non ritrovo questo stesso marcatore, significa che non proviene da quella zona”.
I marcatori evidenziati con l’applicazione delle tecniche omiche possono essere quindi utilizzati, come in questo caso, per definire l’origine geografica di un prodotto, oppure la sua qualità (per esempio per individuare una molecola che è sempre presente quando il caffè viene apprezzato, o una che invece è associata al gusto
rancido delle nocciole), o ancora possono essere collegati a un effetto antiossidante degli alimenti.
“Tramite le tecniche omiche”, commenta Lucini, “si ottengono dataset molto ampi, quelli che chiamiamo i big data, che vanno poi interpretati per capire quali sono le differenze tra due condizioni di alta e bassa qualità, tra un prodotto originale e uno adulterato, tra uno sano e uno difettato. Gli ambiti di applicazione sono davvero ampi. Questi marcatori, infatti, possono essere utilizzati per difendere il consumatore, per pensare come disegnare nuovi alimenti che siano più salutari o siano più apprezzati…. Insomma si possono utilizzare in funzione dello scopo. La potenzialità di queste tecniche è veramente alta, perché quando si hanno a disposizione tantissime informazioni e si è capaci di interpretarle correttamente è possibile applicarle in tantissimi modi”.

IL COSTO, UN LIMITE DA SUPERARE
Le tecniche omiche sono quindi destinate a diventare i metodi di riferimento per l’analisi dei prodotti alimentari? Probabilmente non nell’immediato, a causa del loro costo e della complessità nell’interpretare i risultati.
“La strumentazione che serve per generare una tale mole di dati,” precisa Lucini, “può costare 8-10 volte più degli analoghi strumenti utilizzati per analisi più tradizionali. Inoltre l’analisi statica dei dati raccolti richiede delle competenze di livello elevato in questo ambito. Per questi motivi per ora si tratta di tecnologie nuove, la cui diffusione è per lo più limitata in ambito di ricerca, ma devo dire negli ultimi anni anche alcune aziende molto strutturate, i big player dell’industria ali-
mentare, cominciano ad adottare queste metodiche, così come i laboratori degli Enti deputati al controllo degli alimenti. Le grandi aziende possono impiegarle nella ricerca e sviluppo, per mettere a punto dei prodotti che possano rispondere il più possibile ai benefici richiesti dal mercato, ma anche per verificare le caratteristiche qualitative delle materie prime al momento del conferimento; le autorità di controllo per individuare frodi in commercio messe in atto a danno del consumatore”.
Nonostante i costi Luigi Lucini auspica una maggiore diffusione di questo approccio analitico. “La tecnologia”, afferma, “va a vantaggio dell’azienda che lavora bene e del consumatore. C’è da augurarsi che i costi si abbassino e che
queste tecniche diventino più accessibili e quindi siano più impiegate”.
TECNICHE OMICHE E BIOLOGICO, UN CASO
Le tecniche omiche sono al centro del progetto di ricerca “Omic technologies for consumer food engagement: innovazione nella tracciabilità degli alimenti biologici e fiducia del consumatore”, realizzato da EngageMinds Hub - Consumer, Food & Health Research Center, e finanziato dall’Università Cattolica tra gli indirizzi di ricerca a interesse strategico, con la collaborazione interdisciplinare di diverse facoltà e dipartimenti dell’Ateneo. Il progetto ha l’obiettivo di indagare la percezione dei consumatori in merito all’idea dell’impiego delle tecnologie omiche
a favore della tracciabilità e valutazione nutrizionale delle verdure e della frutta biologiche, richiamando l’attenzione sulle principali implicazioni in termini di salute e sostenibilità di questo tipo di innovazioni. Negli ultimi anni, è aumentata la richiesta da parte dei consumatori di cibi biologici. Nel mese in cui sono state effettuate le rilevazioni, il 40% degli italiani ha consumato prodotti di questo tipo almeno tre o quattro volte a settimana; i più amanti del genere sono i giovani (62%), i laureati (47%), e le persone originarie delle regioni del Sud e Isole (48%).
In particolare, gli alimenti biologici più consumati dagli italiani sono le uova fresche (69%), gli ortaggi (66%) e la frutta (62%), scelti poiché considerati salubri, naturali e rispettosi dell’ambiente. È infatti opinione diffusa che i cibi biologici contengano meno pesticidi e siano prodotti con processi che prestano una particolare attenzione alla sicurezza. Tuttavia, il consumatore non è poi così preparato rispetto alle certificazioni biologiche e per questo motivo può essere indotto in errore negli acquisti.
È a questo punto che entrano in gioco le tecnologie omiche, che permettono di valutare se un prodotto alimentare è davvero biologico, andando a considerare alcuni parametri che le certificazioni “tradizionali” non valutano, per esempio come l’alimento viene conservato e trasportato.
La tracciabilità degli alimenti, in questo contesto, è considerata uno strumento importante per garantire la qualità e la sicurezza alimentare, caratteristiche che possono influenzare l’acquisto da parte dei consumatori.
“Dallo studio,” spiega Greta Castellini, ricercatrice di Psicologia dei Consumi presso la Facoltà di Scienze Agrarie, Alimentari e Ambientali dell’Università Cattolica, “emerge che la maggior parte degli italiani (79%) non ha mai sentito parlare delle tecnologie omiche applicate al cibo. Dopo aver presentato e spiegato dettagliata-
mente tali tecnologie e il loro potenziale ai partecipanti dello studio, questi ultimi le hanno considerate interessanti (54%), positive (58%) e non pericolose (55%).
Tuttavia, sembrano emergere delle incertezze riguardo alla necessità di introdurre queste nuove tecnologie alimentari”. Infatti, il 43% ritiene che l’utilizzo delle tecnologie omiche possa essere evitato in quanto non necessario ai fini della certificazione biologica di un alimento.
In media, il campione dell’indagine ha affermato di essere disposto a pagare circa il 9% in più per gli ortaggi certificati con tecnologie omiche rispetto a quelli non certificati con tali tecnologie.
“Ad oggi le certificazioni a supporto sono principalmente cartacee,” sostiene Luigi Lucini, “e quindi più facilmente soggette a frodi, si auspica quindi il ricorso nei prossimi anni a queste nuove tecnologie omiche, quantomeno in un’ottica di verifiche a campione”.
“Tecnologico e biologico è un binomio che può suonare stridente per il consumatore,” dichiara Guendalina Graffigna, direttrice di EngageMinds Hub - Consumer, Food & Health Research Center, Centro di ricerca in psicologia dei consumi e della salute dell’Università Cattolica, campus di Cremona e coordinatrice del progetto, “in generale più incline ad assimilare le tecnologie alimentari a un concetto di artefazione invece che percepirle come alleate per migliorare la sicurezza di un alimento. Dallo studio che abbiamo condotto, le evidenze raccolte indicano che è fondamentale implementare programmi di educazione e sensibilizzazione rivolti ai consumatori al fine di alfabetizzare sui processi di certificazione del biologico e accrescere la fiducia verso l’adozione di avanzate tecniche di analisi, quali quelle omiche, a favore della tutela dei consumatori”.
“I risultati della ricerca,” aggiunge Giulia Sesini, dottoranda presso la Facoltà di Psicologia dell’Università Cattolica, “eviden-
ziano il ruolo centrale della fiducia negli enti certificatori per stimolare l’adozione delle nuove tecnologie alimentari, senza dimenticare l’importanza ricoperta dagli atteggiamenti verso il cibo più in generale”. I consumatori attribuiscono infatti una crescente rilevanza alla componente etica dei prodotti, fattore determinante nella scelta di cibi certificati tramite nuove tecnologie”. “Da un punto di vista psicologico,” sottolinea, “è inoltre fondamentale differenziare i consumatori in base alle proprie abitudini di consumo per dare forma a una comunicazione mirata e personalizzata che vada a rassicurare in particolar modo i consumatori di cibi biologici sull’integrità del prodotto”.
“Anche i dati raccolti attraverso uno studio sperimentale,” afferma Paola Iannello, docente della Facoltà di Psicologia dell’Università Cattolica, “confermano una certa apertura tra i consumatori nei confronti dell’introduzione delle tecnologie omiche. I risultati, infatti, mettono in evidenza che i prodotti etichettati come omici vengono mediamente valutati, sia dal punto di vista estetico che del gusto, in maniera del tutto simile ai prodotti etichettati come biologici. Anche l’intenzione di acquisto espressa dai consumatori nei confronti dei prodotti omici e biologici è pressoché la medesima, ed è decisamente più elevata rispetto all’intenzione di acquisto espressa nei confronti dei prodotti ‘convenzionali’. Favorire nella percezione del consumatore questa ‘vicinanza’ potrebbe rivelarsi una modalità funzionale ed efficace per introdurre sul mercato prodotti alimentari certificati attraverso le tecnologie omiche”.
Insomma, i presupposti a un maggiore impiego delle tecniche omiche ci sarebbero, anche se oltre a superare le barriere di costo, sarà necessario comunicare correttamente come e perché si utilizzano, per vincere le resistenze del consumatore.

a cura della Redazione
Cereal Docks, che sempre più, dal concetto di “alimentare” guarda a quello di “nutrire” presenta la nuova linea di ingredienti HeliaPRO, e in particolare la nuova farina proteica di semi di girasole. La farina proteica HeliaPRO è naturalmente ricca di proteine e fibre, caratterizzata da un processo di produzione pulito e naturale che garantisce un alto contenuto proteico. Inoltre, è priva di allergeni e proviene da coltivazioni non OGM e originarie dell’Unione Europea. Presenta
un colore e un gusto neutri, rendendola versatile per molteplici applicazioni, tra cui prodotti da forno, snack, pasta senza glutine, polpette vegetali, salse e creme spalmabili.
CEREAL DOCKS www.cerealdocks.it


La serie X6, composta dai sistemi di ispezione a raggi-X X16 e X36.2, presenta una gamma di nuove funzionalità che offrono un’accurata rilevazione di contaminanti su una o più linee. Entrambe le soluzioni sono in grado di ispezionare prodotti di dimensioni medio-grandi (500-600 mm di lunghezza), ottimizzando al contempo la produttività grazie a miglioramenti del design di facile utilizzo.
Il sistema X16 è una soluzione a raggi-X di livello base per prodotti di dimensioni medio-grandi con un rilevatore HiGain, che offre un’eccellente rilevazione di contaminanti come metallo, vetro, pietre, ossa e materiali a bassa densità su linee singole o multiple. Il sistema, in grado di supportare prodotti fino a 300 mm di altezza con velocità del nastro fino a 60 metri al minuto, esegue anche ulteriori controlli di qualità e integrità, migliorando la sicurezza del prodotto al di là della semplice rilevazione di contaminanti. Questi controlli includono il monitoraggio del corretto posizionamento dei prodotti, il conteggio dei componenti in massa, il livello di riempimento e l’identificazione delle confezioni danneggiate. Il sistema X16 è progettato per ottimizzare la produttività grazie
alla sua interfaccia utente intuitiva, alle procedure di pulizia semplificate e ai sottosistemi affidabili, che riducono i costosi tempi di fermo. Per le esigenze di ispezione più avanzate, il sistema X36.2 offre funzionalità di rilevazione di alto livello per prodotti confezionati di dimensioni medio-grandi. Grazie alla tecnologia del rilevatore HiGain+ e al software ContamPlus™, il sistema X36.2 offre controlli di completezza e integrità, identificando piccoli contaminanti e prodotti mancanti o rotti. Il sistema è altamente personalizzabile, con configurazioni a linea singola o multilinea e numerose opzioni di contenitori degli scarti. È in grado di gestire una produttività ancora più elevata con velocità fino a 100 metri al minuto e ha la capacità di gestire oltre 1.000 prodotti al minuto, a seconda delle dimensioni del prodotto. Sia il sistema X16 che il sistema X36.2 sono dotati di importanti aggiornamenti mecca-


nici rispetto alle soluzioni precedenti, oltre a un design completamente nuovo che migliora la rimozione del nastro e semplifica le procedure di assistenza e manutenzione. Questi miglioramenti del design consentono agli operatori di pulire i sistemi ed eseguirne la manutenzione in modo rapido, riducendo al minimo i tempi di fermo. Il design igienico con apertura frontale consente un facile accesso durante la pulizia e la manutenzione, mentre il nastro trasportatore può essere rimosso rapidamente senza la necessità di attrezzi, aumentando l’efficienza di queste procedure.
METTLER TOLEDO www.mt.com
RealMan Robotics presenta all’Advanced Manufacturing Madrid 2024 in Spagna i suoi ultimi bracci robotici, un modello articolato e piattaforme di intelligenza incorporata.
Il braccio robotico della serie ECO65 è caratterizzato da un design leggero e da una tecnologia ad alta efficienza energetica, che garantisce prestazioni ottimali con un consumo energetico ridotto. È adatto per una varietà di applicazioni industriali, come l’assemblag -
gio, la movimentazione e la saldatura, e può migliorare la produttività e ridurre i costi.
La serie RM di bracci robotici umanoidi ultraleggeri di punta di RealMan vanta alta velocità, precisione, flessibilità e affidabilità. È ideale per scenari come la vendita al dettaglio, la ristorazione intelligente, l’assemblaggio di componenti elettronici e le ispezioni intelligenti, aumentando significativamente la produttività e riducendo i costi operativi.


www.realman-robotics.com
Emerson ha lanciato la sua nuova soluzione Energy Manager, un’offerta di hardware e software pre-ingegnerizzati progettata per semplificare il monitoraggio dell’elettricità in ambito industriale con una configurazione rapida e un funzionamento intuitivo. La soluzione Energy Manager viene fornita già pronta all’uso e monitora l’utilizzo di energia degli asset in tempo reale, consentendo ai produttori di ottenere informazioni più approfondite sui consumi di energia e sui costi operativi, riducendo le emissioni di anidride carbonica (CO2) e ottimizzando l’efficienza energetica e operativa.
La dashboard del software di facile utilizzo evidenzia l’utilizzo di energia, i costi associati e le emissioni di CO 2 per ogni asset per un massimo di 10 end point (espandibile a 50 end point con una licenza). Questo livello di visibilità conferisce alle organizzazioni un maggiore controllo per l’individuazione delle macchine inattive e l’ottimizzazione dei programmi delle macchine per le ore non di punta, riducendo l’utilizzo di elettricità nell’intero impianto e tagliando significativamente i costi complessi -


vi delle utenze. La maggior parte delle strutture riesce a ridurre gli sprechi di energia fino al 10-30% e le emissioni di carbonio fino al 15-30%.
Altamente scalabile e facile da integrare con misuratori di utilizzo dell’energia nuovi o esistenti, la soluzione Energy Manager semplifica la messa in servizio e consente di realizzare rapidamente un ritorno sull’investimento. Il software è disponibile sia preinstallato su hardware edge, come il PC industriale PACSystemsTM RXi2-BP oppure come applicazione autonoma da installare in un ambiente virtualizzato.
EMERSON www.emerson.com
I motori sincroni IE5+ NORD veri e propri punti di riferimento in termini di efficienza energetica e affidabilità, offrono una potenza da 0,35 kW a 4 kW e superano ampiamente la classe di efficienza IE4. I motori sincroni IE5+, compatti e versatili, sono disponibili in diverse configurazioni: lisci TENV, con raffreddamento TEFC o con motoriduttore integrato DuoDrive. Grazie a rendimenti fino al 95% su un’ampia gamma di coppia, assicurano un’efficienza energetica ottimale anche a carico parziale. In combinazione con gli inverter NORDAC, i motori IE5+ costituiscono uno dei sistemi di azionamento più performanti sul mercato. Il NORDAC PRO SK 500P è l’inverter da quadro elettrico ideale per un’ampia gamma di applicazioni. Disponibile fino a 22 kW e presto estendibile a 160 kW, questo inverter compatto e robusto supporta ca-

richi elevati e offre prestazioni eccezionali. Grazie alle interfacce USB, multi-encoder e Ethernet multi-protocollo, si integra facilmente in qualsiasi sistema di controllo. Il PLC integrato e la funzione POSICON semplificano la gestione di compiti com-

Per rispondere alle crescenti esigenze di sicurezza RWC ha sviluppato una nuova generazione di Valvole Anti-Legionella, progettate per prevenire la proliferazione del batterio all’interno degli impianti idrici, grazie alla generazione di movimento che impedisce il ristagno. Queste valvole si caratterizzano per un design innovativo, in linea con gli altri prodotti del marchio RWC Reliance Valves, e sono ora disponibili in quattro nuove misure (½”, ¾”, 1” e 1¼”), che le rendono compatibili con una più ampia gamma di vasi di espansione. Rispetto ai modelli precedenti, le nuove valvole sono più facili da installare e richiedono meno manutenzione. Inoltre, i modelli da 1” e 1¼” sono dotati di una maniglia con serratura, pensata per impedire manomissioni e garantire maggiore sicurezza. Le Valvole Anti-Legionella Reliance Valves fanno parte della gamma RWC di soluzioni per il settore termosanitario, che include
plessi, mentre la compatibilità con tutti i tipi di motori riduce la complessità dell’armadio elettrico.
NORD DRIVESYSTEMS www.nord.com


anche vasi di espansione per uso alimentare, valvole di miscelazione termostatiche (TMV) e valvole di bilanciamento termico (TBV).
Lory® Starch Elara ha un contenuto di fibre del 90% ed è ampiamente indigeribile dal corpo umano. Sostituendo parzialmente la farina o la semola, i produttori possono produrre prodotti da forno ad alto contenuto di fibre come muffin, toast e pizza, nonché prodotti di pasta con un contenuto di carboidrati inferiore. Poiché la fibra contiene solo circa 2 kcal/g rispetto alle 4 kcal/g dei carboidrati, il conteggio calorico complessivo può essere ridotto significativamente utilizzando Lory® Starch Elara. L’amido di frumento è una polvere insapore e inodore con una capacità di legare l’acqua molto bassa. Le inclusioni perfette per formulazioni arricchite di nutrienti sono Lory® Protein H11 e D11, entrambe parte della gamma Lory® Protein, nonché la polvere estrusa Lory® Tex. Sono ricche di proteine e dal sapore neutro, il che le rende ideali per l’arricchi-


mento proteico in prodotti da forno come pane, pizza, biscotti e biscotti, nonché prodotti di pasta. Lory® Protein D11 è una proteina di grano estrusa e denaturata, mentre Lory® Protein H11 è idrolizzata e può migliorare l’estensibilità degli impasti ad alto
Lo scopo dell’automazione del settore vitivinicolo è quello di rendere più facile ed efficiente in termini di costi la piena realizzazione della visione unica di ogni produttore. Ma sebbene i vantaggi dell’automazione siano ormai acclarati e numerosi, la transizione non è sempre facile per i diversi operatori di questo comparto dove, forse più che in altri, è particolarmente impegnativo trovare un equilibrio tra tradizione e tecnologia. Il timore più diffuso è che l’automazione interferisca con l’artigianalità della coltura della vigna e della vinificazione.
Ad esempio, installando dei sensori su un serbatoio di fermentazione, le cantine possono monitorare l’andamento del processo in tempo reale. Il valore del grado Brix si popola automaticamente con questi dati utilizzando il software moneo di ifm sul computer portatile, in modo da poter visualizzare la lavorazione in corso. Questo
contenuto di glutine. Entrambe le varietà sono stabili al pH e al calore, garantendo prestazioni ottimali durante la produzione.
LORYMA
www.crespeldeitersgroup.com/loryma


costante controllo fornisce così dati utili all’enologo, il quale può verificare la curva del valore grado Brix e intervenire per le correzioni necessarie. L’automazione, inoltre, riduce il rischio di errore nei processi manuali e consente maggiore efficienza, ridimensionando la necessità di manodopera per attività basiche e quindi lasciando spazio a competenze di maggior valore. In-
fine, ma non meno importante, contribuisce a un approccio sostenibile della produzione: utilizzare dati rilevati just in time, come i consumi energetici e di acqua, porta a una migliore gestione e conservazione delle risorse.
www.ifm.com

Francesco Nicassio
Dottore forestale esperto in gestione integrata degli infestanti

Francesco Fiorente
Dottore forestale esperto in gestione integrata degli infestanti
Il lavoro dei disinfestatori è in costante evoluzione e, indubbiamente, ci sono circostanze che potrebbero complicarlo: mutano le leggi, diminuiscono le sostanze attive disponibili, gli adempimenti sono complessi e articolati e il mercato, infine, richiede maggiore attenzione, anche sotto il profilo delle certificazioni. Di contro, vi sono fattori che dovrebbero o potrebbero semplificarlo: nuove strategie di lotta integrata, attrezzature sempre più “smart”, formulati più performanti e, non ultimo, software gestionali che diventano un ausilio sempre più importante, sia per la semplificazione dell’attività documentale che per la miglior pianificazione del lavoro. Esistono, poi, fattori esterni, globali, di cui non sempre siamo in grado di considerare l’impatto: il clima e la globalizzazione. Cosa c’entrano questi ultimi con il nostro
discorso? Come il cambiamento climatico e il trasporto di merci e persone possono influire sulle specie animali e vegetali presenti in un territorio e, in particolare, sul lavoro dei disinfestatori professionali?
Al riguardo, sempre più spesso sentiamo parlare di “specie aliene invasive” o di “specie alloctone invasive”.
Le “specie aliene invasive” sono organismi introdotti dall’uomo, intenzionalmente o accidentalmente, al di fuori del loro habitat naturale, che minacciano la biodiversità locale. Allo stesso tempo, costituiscono un rischio anche per le attività umane, come l’agricoltura o la tutela della salute. Secondo il Regolamento (UE) n. 1143/2014, sono definite come specie esotiche invasive quelle il cui impatto negativo richiede un intervento coordinato a livello dell’Unione europea. Questi organismi
possono includere insetti, piante, mammiferi e altri tipi di flora e fauna che, grazie alla loro adattabilità, trovano nei contesti antropici opportunità ideali per crescere e riprodursi.
In un mondo sempre più connesso, dove le merci vengono costantemente trasportate da un capo all’altro (ma anche in gli spostamenti delle persone sono certamente più semplici), è probabile che gli insetti più adattabili si diffondano e diventino “cosmopoliti”; l’Italia poi, nazione ospitale, risulta particolarmente vulnerabile a questo genere di colonizzazioni; pensiamo alla zanzara tigre (Aedes albopictus), alla cimice asiatica (Halyomorpha halys), al coleottero giapponese (Popillia japonica), alla cocciniglia tartaruga (Toumeyella parvicornis), al punteruolo rosso delle palme (Rhynchophorus ferrugineus), solo per citarne alcuni.

I danni derivanti, nella sola Italia, dall’introduzione della cimice asiatica in agricoltura nel 2012, sono stati ingenti, specialmente nel 2019. In quell’anno, le perdite stimate hanno superato i 740 milioni di euro, con alcune colture che hanno registrato perdite fino al 100%.
Dal punto di vista della salute pubblica, l’impatto delle zanzare AIM (Aedes Invasive Mosquitoes: negli ultimi anni sono state segnalate in Italia Ae. japonicus e Ae. koreicus, se dimenticare il rischio di introduzione della nota Ae. aegypti), provenienti da aree lontane dall’Unione europea, sta costituendo a livello globale una minaccia importante per la salute delle persone e degli animali, per la diffusione di arbovirosi. Il riscaldamento globale, inoltre, favorisce la diffusione di insetti invasivi dannosi per la salute umana e le attività economiche. L’aumento delle temperature estende l’habitat di vettori come zanzare e zecche, incrementando il rischio di malattie trasmesse all’uomo e agli animali. Inoltre, il cambiamento climatico amplia le aree di distribuzione di insetti nocivi per l’agricoltura, minacciando la sicurezza alimentare. La tematica non è nuova in assoluto: già Charles Darwin comprese che alcune specie possono essere un pericolo, per esempio, per la biodiversità. Nel 1834, ri-
levò che il ratto grigio aveva di fatto avuto un impatto negativo sulle popolazioni di ratti preesistenti in Nuova Zelanda (a loro volta introdotte dai Maori qualche secolo prima).
Quando questi organismi si adattano a vivere in stretta vicinanza e rapporto con gli uomini, vengono definite “sinantropiche”. Le specie sinantropiche spesso sfruttano le modifiche ambientali apportate dall’uomo, come l’aumento delle temperature nelle città, la disponibilità di rifiuti come fonte di cibo, e la mancanza di predatori naturali.
Un esempio classico di specie sinantropica è la blattella germanica, che infesta abitazioni, ristoranti, panifici, industrie alimentari, bar e locali pubblici sostanzialmente ovunque nel mondo; a ben guardare, non è un caso se tra le specie di insetti sinantropici cosmopoliti vi siano numerose blatte. Le blatte - comunemente conosciute come scarafaggi - sono tra gli insetti più adattabili e resilienti del pianeta; riescono a colonizzare numerose nicchie ecologiche e, spesso, pur vivendo a stretto contatto con l’uomo, risultano “invisibili”. La loro presenza diventa manifesta quando, grazie alla loro veloce capacità riprodut-
tiva, entrano in competizione alimentare e, costretti dalla fame e dalla mancanza di spazio, devono trovare nuovi punti di approvvigionamento trofico e di colonizzazione.
Ma gli scarafaggi sono tutti sinantropici e commensali dell’uomo?
L’ordine delle Blatte comprende 6 famiglie con 460 generi e oltre 4.000 specie; sono insetti cosmopoliti che vivono pressoché ovunque eccetto che nelle regioni polari e ad altitudini superiori ai 2.000 m. Delle oltre 4.000 specie presenti al mondo, solo una quarantina sono considerate sinantropiche o commensali dell’uomo e, di queste, solo 4 sono infestanti di interessa sanitario e merceologico in Italia: Blattella germanica (fuochista o mangiapane), Blatta orientalis (scarafaggio nero), Periplaneta americana (blatta americana), Supella longipalpa (blatta dei mobili).
Di fatto, quindi, in Italia vi è circa un decimo delle specie di blatte sinantropiche presenti al mondo. Potrebbero arrivarne altre? Potremmo, tra qualche anno, ritrovarci ad attuare strategie di lotta a blatte ad oggi ancora sconosciute?
Una domanda sorge spontanea: chi individua l’arrivo di nuovi insetti in un territorio?
Molto spesso le Università, le quali ricevono campioni da cittadini curiosi e attenti

e procedono con l’identificazione; negli ultimi anni, le app di riconoscimento “naturalistico” stanno contribuendo in questo genere di campionamenti. Alle volte, sono gli operatori del settore, come è successo nell’esempio sotto riportato.
Nella primavera del 2024, il sig. Luigi Cotumaccio, tecnico specializzato dell’impresa Iside S.r.l, fornitore professionale di servizi di pest management, svolgendo le sue normali attività di disinfestazione e monitoraggio presso il “CIS di Nola la città degli affari”, nota su alcuni supporti collanti impiegati per le attività di monitoraggio un’importante presenza di una blatta diversa da quelle solitamente rinvenute. Nel corso dei mesi, rileva che la stessa blatta è presente anche presso altri siti da lui seguiti: interporto di Nola (NA), interporto di Maddaloni (CE) e zona industriale di Carinaro (CE). Incuriosito, il sig. Luigi reperta alcuni campioni perché vengano identificati e - tramite la CEO dell’azienda per cui opera, Emanuela Ascione - gli stessi pervengono al dr. Francesco Nicassio, esperto del settore disinfestazioni e consulente di entomologia urbana e merceologica. Il
riconoscimento delle blatte è stato effettuato dallo stesso dr. Nicassio presso i laboratori dell’Università degli Studi di Bari, per mezzo delle chiavi di riconoscimento dei generi di Blattidae, noti in Italia e nel resto d’Europa. Si è così stabilito trattarsi di una blatta che, sebbene capillarmente
presente nei negozi di cibo per animali e nelle case di appassionati erpetologi, solo da pochi anni vive in natura in limitate zone d’Italia. Infatti, tra i campioni vi erano sia adulti (maschi e femmine), che neanidi e ooteche, consentendo di identificarli come appartenenti alla specie Shelfordella lateralis (Walker), conosciuta anche come Blatta lateralis o “Turkestan Cockroach”. La blatta laterale è una delle specie più diffuse e allevate nel settore hobbistico, tra gli allevatori di animali insoliti, come rettili e anfibi o uccelli insettivori; vengono solitamente utilizzate come cibo vivo per sauri. La loro prolificità e facilità di gestione casalinga la rendono estremamente comune ma anche, nel caso assai probabile in cui alcuni esemplari dovessero sfuggire dall’allevamento casalingo, estremamente pericolosa e diffusiva. Questa, molto probabilmente, è stata la via di diffusione e di ingresso in molti paesi compresa l’Italia. Originaria probabilmente delle zone desertiche e semi-desertiche dell’Asia medio orientale, è diffusa anche in Africa Nordorientale, India e Asia centrale (AL-Houty, 2011). A partire dagli anni ’70, è presente anche negli Stati Uniti, Giappone e Mes-


sico, mentre solo negli ultimi anni appare anche a Cipro, in Turchia (Davranoglou et al. 2020) e nella penisola Iberica (Pradera & Carcereny, 2018).
Qual è però la situazione in Italia?[1] A seguito delle prime segnalazioni in Sardegna nel 2009 (Fois et al., 2009), ve ne sono diverse più recenti:
§ in Veneto, sia nella città di Vicenza, che a Santa Maria di Sala (VE), negli anni dal 2018 al 2022;
§ in Lombardia, a Galbiate (LC) nel 2022;
§ in Lazio, a Roma e Pomezia nel 2022.
BIOLOGIA ED ETOLOGIA
DELLA SHELFORDELLALATERALIS
Sono blatte di medie dimensioni; raggiungono i 3 cm con dimorfismo sessuale piuttosto evidente. Il maschio ha una colorazione marrone chiaro ed è alato, mentre le femmine, decisamente più scure, sono di colore rosso e arancione scuro.
Sono piuttosto veloci nei movimenti ma non sono delle grandi arrampicatrici, non riescono a superare pareti lisce. Sono onnivore, possono nutrirsi di sostanze vegetali, come di proteine animali. Tendenzialmente vivono all’esterno nelle vicinanze delle abitazioni ma, in alcuni casi, possono infestare le case esattamente come la Blattella germanica. Il ciclo biologico alla temperatura di 25°C30°C si completa in 3-5 mesi e le femmine adulte fecondate depongono 1 ooteca da circa 20 uova ogni 15 giorni. Gli adulti vivono circa 1 anno.
Sherfoldella lateralis , conosciuta anche come Blatta lateralis o Turkestan Cockroach, è una specie di scarafaggio che può trasmettere diverse malattie a causa della sua presenza in ambienti umani e animali.
Questo scarafaggio è particolarmente pericoloso perché può diffondere patogeni
come batteri, virus e parassiti che possono causare gravi problemi di salute.
Sherfoldella lateralis è potenziale vettore di malattie che includono infezioni batteriche come quelle causate da Staphylococcus, che possono portare a infezioni cutanee, polmonari e altre complicazioni. Inoltre, questi scarafaggi possono trasportare parassiti intestinali come i nematodi, che possono infettare sia gli esseri umani, che gli animali domestici.
I rischi legati alla presenza di Sherfoldella lateralis risiedono nella sua capacità di diffondersi rapidamente e di sopravvivere in ambienti diversi, compresi quelli urbani e rurali. La loro presenza in cucine, bar, ristoranti, forni e pasticcerie e altre aree dove si conservano alimenti può portare a contaminazioni alimentari e a gravi rischi per la salute pubblica. Cosa succederà nei prossimi anni? Ci ritroveremo a effettuare trattamenti anche per questa nuova blatta o ne arriveranno di nuove ancora non identificate sul suolo italiano? Di sicuro sarà necessario, per i disinfestatori (dai responsabili tecnici ai tecnici operanti in campo, sino a tutto il personale di supporto) e tutte le parti interessate a questo argomento, continuare ad aggiornarsi e formarsi; solo una adeguata preparazione consentirà di superare le innumerevoli sfide che la lotta agli insetti ci offre.
[1] Primi dati sulla presenza di shelfordella lateralis (walker, 1868) (blattodea: blattidae) nell’Italia continentale e possibili scenari di espansione futura in europa (Roberto Battiston, Paolo fontana, Marco Vicariotto, 2022).
Alla luce delle sfide globali che l’industria alimentare è chiamata ad affrontare, AlimentiPiù ha tracciato gli scenari di mercato e di consumo, con un’attenzione ai temi della sostenibilità delle filiere tecnologie della
www.alimentipiu.it
info@alimentipiu.it

Nel comparto alimentare assistiamo al periodico emergere di alcuni infestanti che talvolta tornano nell’anonimato nel volgere di poco tempo e tal altre volte no, anzi si affermano e si espandono. È recente il caso di Nemapogon granellus nella produzione casearia e Piophila casei nei prosciuttifici.
Negli stessi anni, a far capo dal 2015, è stata certificata la diffusione di Necrobia rufipes (Coleoptera: Cleridae) in particolare nell’industria del pet food [1], dove possiamo incontrare anche alcune specie del genere Dermestes con i quali condividono la dieta proteica del cleride.
N. rufipes oggi è all’origine di infestazioni importanti anche nell’industria del prosciutto crudo di alta qualità, sommandosi al problema P. casei, dove, invece,

non sembra ripetersi la coabitazione con Dermestes spp., probabilmente più termofilo.
Le possibilità di contrasto a questi infestanti, una volta insediati, sono limitate e come buona norma generale è opportuno porre i cardini del controllo su prevenzione, sorveglianza, individuazione dei focolai, la loro eliminazione e pulizia generale. A rendere complicata la sorveglianza è la limitatezza degli strumenti di monitoraggio disponibili, i quali devono essere impiegati in modo ottimale. N. granellus è l’unica specie per la quale disponiamo di un feromone sessuale, ma le basse temperature d’impiego possono limitarne la diffusione e il raggio d’azione, quindi è necessario disporre di una razionale rete di trappole.
Allo stesso modo gli attrattivi alimentari e le trappole studiati nei laboratori


GEA per P. casei, N. rufipes e Dermestes spp. devono essere collocate in numero e posizioni adeguate tenendo presente, oltre a una diminuzione delle emissioni delle sostanze volatili, anche la competizione degli alimenti presenti.
Infine, i dispositivi UV, molto efficaci per la cattura di P. casei e N. granellus, raggiungono la massima efficacia se installati a livello del pavimento o al massimo a 1 m di altezza.
INPEST www.inpest.it
[1] Savoldelli S., Frignani M., Süss L., Necrobia rufipes (De Geer): an emerging pest associated with pet store chain in Europe. 12th International Working Conference on Stored Product Protection (IWCSPP) in Berlin, Germany, October 7-11, 2018

Avv. Chiara Marinuzzi
Studio Legale Gaetano Forte
IMPORTANTI NOVITÀ IN VISTA
Èdel 22 gennaio 2025 la pubblicazione sulla GUUE del Regolamento (UE) 2025/40 sugli imballaggi e i rifiuti di imballaggio (Packaging and Packaging Waste Regulation): una vera e propria rivoluzione normativa finalizzata ad ambiziosi obiettivi di sostenibilità ambientale.
Figlio del Green Deal europeo e del nuovo piano d’azione per l’economia circolare per un’Europa più pulita e più competitiva ha come primo obiettivo di ridurre significativamente la produzione di rifiuti di imballaggio del 5% entro il 2030, del 10% entro il 2035 e del 15% entro il 2040, in particolare i rifiuti di imballaggio in plastica.
L’applicazione è al 12 agosto 2026, fatte salve le diverse scadenze temporali ivi indicate.
Il testo è imponente: 71 articoli e XIII allegati tecnici, cui seguiranno specifici atti di esecuzione della Commissione, e prevede:
Riduzione del peso e delle tipologie non necessarie di imballaggi
L’obiettivo verrà raggiunto limitando principalmente la quantità dei materiali (plastica, vetro, carta, alluminio etc.) dispersi.
Entro il 1° gennaio 2030 il fabbricante o l’importatore provvede affinché l’imballaggio immesso sul mercato sia progettato in modo che il suo peso e il suo volume siano ridotti al minimo necessario per garantirne la funzionalità, tenendo conto della forma e del materiale di cui è costituito.
Riciclabilità e contenuto riciclato
Entro il 1° gennaio 2030, tutte le parti di plastica di un imballaggio immesso sul mercato contengono la seguente percentuale minima di contenuto riciclato recuperato da rifiuti di plastica post-consumo calcolata come media per impianto di produzione e per anno:
a) 30% per gli imballaggi sensibili al contatto il cui componente principale è il polietilentereftalato (PET), ad eccezione delle bottiglie monouso per bevande;
b) 10% per gli imballaggi sensibili al contatto realizzati con materie plastiche diverse dal PET, ad eccezione delle bottiglie di plastica monouso per bevande;
c) 30% per le bottiglie di plastica monouso per bevande;

d) 35% per gli imballaggi di plastica diversi da quelli di cui alle lettere a), b) e c).
Entro il 1° gennaio 2040 tutte le parti di plastica di un imballaggio immesso sul mercato contengono la seguente percentuale minima di contenuto riciclato recuperato:
a) 50% per gli imballaggi sensibili al contatto il cui componente principale è il polietilentereftalato (PET), ad eccezione delle bottiglie monouso per bevande;
b) 25% per gli imballaggi sensibili al contatto realizzati con materie plastiche diverse dal PET, ad eccezione delle bottiglie monouso per bevande;
c) 65% per le bottiglie di plastica monouso per bevande;
d) 65% per gli imballaggi di plastica diversi da quelli di cui alle lettere a), b) e c) del presente paragrafo.
Riciclabilità e classi di presentazione
Tutti gli imballaggi immessi sul mercato dovranno essere riciclabili. Un imballaggio è considerato riciclabile se:
a) è progettato per il riciclaggio di materiali in modo da consentire che le materie prime secondarie risultanti siano di qualità sufficiente rispetto al materiale originale per poter essere utilizzate in sostituzione delle materie prime primarie, e b) quando diventa rifiuto, può essere oggetto di raccolta differenziata, cernito in flussi di rifiuti specifici senza compromettere la riciclabilità di altri flussi di rifiuti e riciclato su scala.
Il regolamento prevede diverse decorrenze per tali adempimenti (2030 per le ipotesi della lett. a) e 2035 per la lett b)).
La riciclabilità degli imballaggi sarà espressa mediante le classi di prestazione A, B e C,
Tutti gli imballaggi immessi
con divieto di immissione sul mercato (dal 2030) per quelli senza tale qualificazione. Poi dal 2038 sono ammesse solo le classi A o B.
Etichettatura armonizzata dell’imballaggio
Dal 12 agosto 2028 è obbligatoria un’etichetta armonizzata contenente informazioni sui materiali che compongono l’imballaggio al fine di facilitare la cernita da parte dei consumatori. L’etichetta si compone di pittogrammi ed è facilmente comprensibile, anche per le persone con disabilità.
Possibile, in aggiunta, il ricorso a un codice QR o altro tipo di supporto dati standardizzato, aperto, digitale.
Gli imballaggi soggetti a sistemi di deposito cauzionale e restituzione sono contrassegnati da un’etichetta chiara e inequivocabile.
sul mercato dovranno essere riciclabili

Dal 12 febbraio 2029 è necessario inserire un’etichetta che informa gli utilizzatori del fatto che l’imballaggio è riutilizzabile.
Asserzioni ambientali
Il PPWR ammette le asserzioni ambientali (c.d. green claim) sugli imballaggi se queste: a) sono fornite solo in relazione alle proprietà degli imballaggi che superano le prescrizioni minime applicabili prescritte dal regolamento; e
b) specificano se si riferiscono all’unità di imballaggio, a parte dell’unità di imballaggio o a tutti gli imballaggi immessi sul mercato dall’operatore economico. L’allegato VII del presente regolamento definisce la documentazione tecnica da utilizzare a supporto dei claim.
Identificazione degli operatori economici
Definiti specifici obblighi di rintracciabilità da parte degli operatori, attraverso informazioni sull’identità:
a) di qualsiasi operatore economico che ha fornito loro imballaggi o prodotti imballati;
b) di qualsiasi operatore economico a cui hanno fornito imballaggi o prodotti imballati.
Gli operatori economici devono poter comunicare le informazioni di cui alla lettera a), come segue:
a) nel caso di un imballaggio monouso: per cinque anni dalla data in cui abbiano fornito o sia stato fornito loro l’imballaggio;
b) nel caso di un imballaggio riutilizzabile: per dieci anni dalla data in cui abbiano fornito o sia stato loro fornito loro o l’imballaggio.
Obbligo relativo agli imballaggi eccessivi
Entro il 1° gennaio 2030 gli operatori economici che riempiono imballaggi multipli, imballaggi per il trasporto o imballaggi per il commercio elettronico
garantiscono che la proporzione dello spazio vuoto massimo, espressa in percentuale, non superi il 50%.
Restrizioni all’uso di determinati formati di imballaggio monouso
Sempre dal 1° gennaio 2030 gli operatori economici non immettono sul mercato imballaggi nei formati e per gli utilizzi elencati nell’allegato V del regolamento, quali, ad esempio, imballaggi di plastica monouso per meno di 1,5 kg di prodotti ortofrutticoli freschi preconfezionati (reti, sacchetti, vassoi, contenitori), imballaggi di plastica monouso per alimenti e bevande riempiti e destinati al consumo nei locali del settore alberghiero, della ristorazione e del catering (vassoi, piatti e bicchieri monouso, sacchetti, scatole), imballaggi di plastica monouso del settore alberghiero, della ristorazione e del catering, contenenti porzioni individuali di condimenti, conserve, salse, panna da caffè e zucchero, flaconcini utilizzati in
hotel, bar e ristoranti; borse di plastica ultrasottili per generi alimentari sfusi.
Obiettivi di riutilizzo
Gli operatori che utilizzano imballaggi per il trasporto o imballaggi per la vendita usati per il trasporto di prodotti, anche in caso di commercio elettronico (es pallet, scatole di plastica pieghevoli, vassoi, fusti etc), assicurano che almeno il 40% siano riutilizzabili. Ciò dal 1 gennaio 2030 con passaggio al 70% nel 2040. Analoghe disposizione per gli operatori che usano imballaggi multipli sotto forma di scatole, escluso il cartone, al di fuori degli imballaggi per la vendita per raggruppare un determinato numero di prodotti al fine di creare un’unità di stoccaggio o di distribuzione: il 10% deve essere riutilizzabile dal 2030 e il 25% dal 2040. Per il distributore finale di bevande alcoliche e analcoliche: dal 1° gennaio 2030 10%; 40% dal 2040.
Escluse le bevande considerate altamente deperibili e ai prodotti vegetali sostitutivi del latte, alcune categorie di prodotti vitivinicoli, i prodotti vitivinicoli aromatizzati, i prodotti simili ai prodotti vitivinicoli e ai prodotti vitivinicoli aromatizzati ottenuti a partire da frutta diversa dall’uva e da ortaggi e da altre bevande fermentate, alle bevande alcoliche. Il regolamento identifica specificamente i Codici di nomenclatura combinata di tali prodotti.
Obbligo di ricarica per il settore degli alimenti e delle bevande da asporto
Per il settore Horeca da febbraio 2027, i distributori finali che, utilizzando imballaggi da asporto, mettono a disposizione nel territorio di uno Stato membro bevande calde o fredde garantiscono ai consumatori un sistema che permetta loro di portare il proprio contenitore da riempire. Analoghe disposizioni per gli alimenti pronti.
La pratica del riempimento non deve comportare prezzi superiori o condizioni sfavorevoli per il consumatore.
Offerta di riutilizzo per il settore dell’asporto
Sempre nell’horeca, escluse le microimprese, entro il 12 febbraio 2028, nel caso di asporto, i distributori di bevande calde o fredde o alimenti pronti destinati al consumo immediato, offrono ai consumatori l’opzione di ottenere i prodotti in imballaggi riutilizzabili nell’ambito di un sistema di riutilizzo.
I consumatori sono informati di tale possibilità nel punto di vendita, mediante pannelli informativi o segnaletici chiaramente visibili e leggibili, della possibilità di ottenere i prodotti in imballaggi riutilizzabili.
A decorrere dal 2030 i distributori finali si adoperano per offrire il 10% dei prodotti in vendita in un formato di imballaggio riutilizzabile.
Borse di plastica
Gli Stati membri adottano le misure necessarie per conseguire nel loro territorio una riduzione consolidata del consumo di borse di plastica in materiale leggero.
Prevenzione dei rifiuti di imballaggio
Ciascuno Stato membro riduce i rifiuti di imballaggio pro capite, rispetto ai valori corrispondenti del 2018, almeno del 5% entro il 2030; 10% entro il 2035; 15% entro il 2040.
di riciclaggio e promozione del riciclaggio
Gli Stati membri adottano le misure necessarie per conseguire i seguenti obiettivi di riciclaggio:
a) entro il 31 dicembre 2025 almeno il 65% in peso di tutti i rifiuti di imballaggio prodotti;
b) entro il 31 dicembre 2025, le seguenti percentuali minime in peso dei se-
guenti materiali specifici contenuti nei rifiuti di imballaggio prodotti: 50% per la plastica; 25% per il legno; 70% per i metalli ferrosi; 50% per l’alluminio; 70% per il vetro; 75% per la carta e il cartone;
c) entro il 31 dicembre 2030 almeno il 70% in peso di tutti i rifiuti di imballaggio prodotti;
d) entro il 31 dicembre 2030, le seguenti percentuali minime in peso dei seguenti materiali specifici contenuti nei rifiuti di imballaggio prodotti: 55% per la plastica; 30% per il legno; 80% per i metalli ferrosi; 60% per l’alluminio; 75% per il vetro; 85% per la carta e il cartone.
Il PPWR prevede la valutazione della conformità degli imballaggi nonché la dichiarazione di conformità UE che attesta che è stata dimostrata la conformità alle prescrizioni stabilite dal regolamento.
Il nuovo Regolamento PPWR introduce importanti novità e specifici adempimenti per gli operatori economici. L’obiettivo è la riduzione di rifiuti tramite obiettivi vincolanti di riutilizzo, la limitazione di determinati tipi di imballaggi monouso e imponendo la riduzione al minimo degli imballaggi. Nonostante gli obiettivi di sostenibilità che si pone il regolamento, non sono tuttavia mancate e non mancano polemiche e osservazioni da parte di operatori e associazioni di categoria che intravedono criticità e situazioni che potrebbero non essere semplici da gestire.
L’INDUSTRIA ALIMENTARE È NOTORIAMENTE
ENERGIVORA: DALL’APPROVVIGIONAMENTO DELLE
MATERIE PRIME ALLA LORO LAVORAZIONE, FINO
ALLA CONSERVAZIONE DEGLI ALIMENTI, I PROCESSI
RICHIEDONO COSTANTE APPORTO ENERGETICO PER PRODURRE FREDDO O CALDO. L’IMPATTO AMBIENTALE DI TUTTO QUESTO PUÒ PERÒ ESSERE CONTENUTO
GRAZIE AL MIGLIORAMENTO DEI PROCESSI, DELLA GESTIONE DELLA RISORSA IDRICA E ALL’OPPORTUNITÀ DI RIUSO E RICICLO
Per l’industria alimentare la questione dell’energia e del suo approvvigionamento è centrale; molti processi, dalla raccolta delle materie prime alla loro lavorazione, fino alla conservazione degli alimenti, richiedono costante apporto energetico per produrre, a seconda delle necessità,


temperature fredde o calde. L’impatto ambientale può essere gestito e contenuto con diverse strategie: il miglioramento dei processi, la gestione efficiente dell’acqua, le tecniche di riuso e riciclo e così via. Questi argomenti sono stati al centro di una sessione di AlimentiPiù, dedicata al tema della sostenibilità e dell’efficienza
energetica, con un focus sul ruolo dell’acqua nella filiera agroalimentare. Come spiegato nel suo intervento dalla Tecnologa Alimentare Francesca De Vecchi, che ha moderato l’incontro, l’utilizzo delle risorse è certamente una questione di impatto ambientale, ma per l’industria alimentare diventa anche un tema di ri-

L’impatto ambientale può essere gestito e contenuto con diverse strategie: il miglioramento dei processi, la gestione efficiente dell’acqua e le tecniche di riuso e riciclo qualificazione, ripensamento e miglioramento dei processi.
LA RISORSA IDRICA
Il valore dell’acqua generata dai reflui è stato il focus dell’intervento di Valerio Miceli, Ricercatore presso Enea, l’Agenzia nazionale per le nuove tecnologie, l’energia e lo sviluppo economico sostenibile. Non si tratta purtroppo di una risorsa inesauribile; nel contempo costituisce un elemento fondamentale per la prosperità e la pace, come segnalato in un recente rapporto delle Nazioni Unite. Per queste ragioni le cosiddette sfide idriche devono essere affrontate sulla base della cooperazione tra le comunità e le attività economiche. In questo modo ci saranno benefici per l’agricoltura, si produrrà energia rinnovabile, si garantirà protezione ambientale e riduzione della povertà. A livello europeo, l’Agenda UE al punto 6, trattando di sviluppo sostenibile, parla di “garantire a ogni persona l’accesso all’acqua
potabile e ai servizi igienico-sanitari gestiti in maniera sostenibile”. Il che significa “gestione sostenibile delle risorse idriche, qualità dell’acqua, gestione integrata delle risorse idriche, ecosistemi legati all’acqua in un ambiente favorevole”. Come è evidente, si tratta di obiettivi ancora lontani dall’essere raggiunti in molti Paesi.
Alla base della produzione agricola
Miceli ha fornito una serie di dati molto interessanti sul tema dell’acqua per utilizzo agricolo. A livello mondiale si stima che oggi l’uomo prelevi circa 3600 km cubi di acqua dolce, che è l’equivalente di 580 metri cubi annui pro-capite. Di questi, circa il 70% di tutti i prelievi sono destinati appunto all’uso agricolo, mentre l’uso domestico/civile pesa solo per il 10% e quello industriale per il 21%.
Le cose sono ovviamente differenti nei diversi continenti. In Europa e Nord America la voce principale è quella dell’industria ma, in ogni caso, la produzione agricola dipende sempre dall’accesso e dalla disponibilità dell’acqua e la sua mancanza riduce il potenziale produttivo, i mezzi di sussistenza, la resilienza agli shock e la stessa sicurezza alimentare delle persone.
Dal 1961 al 2018 la superficie irrigata è più che raddoppiata, passando da 139 milioni di ettari a oltre 328 milioni (FAO 2021). Che l’acqua faccia la differenza lo dice anche il fatto che oggi circa il 40% dell’intera produzione agricola arrivi direttamente da terreni irrigati, anche se rappresentano solo il 20% dei terreni agricoli.
Ci sono strategie per migliorare ulteriormente lo stato di cose: le più importanti sono quelle che permettono irrigazione più efficiente, il riutilizzo dell’acqua, la desalinizzazione, e la ricarica degli acquiferi. Un aiuto importante arriva dalla digitalizzazione che

permette agli agricoltori di poter contare su dati accurati e in tempo reale. Questo consente di intervenire in maniera tempestiva e modificare l’apporto idrico in funzione delle condizioni, garantendo efficienza e risparmio dell’acqua.
Valorizzare l’acqua
Esistono diversi metodi o, per usare le parole di Miceli, “sistemi per valorizzare l’acqua”. Il primo, che è una sorta di precondizione, fa riferimento alla cosiddetta impronta idrica, che è fondamentale per essere costantemente informati sull’uso che viene fatto dell’acqua negli stabilimenti e lungo le catene di fornitura. L’impronta misura la quantità effettiva di acqua utilizzata in un processo specifico (o globalmente). Per fare un esempio concreto, è quella che ci dice che la produzione di un chilo di carne di manzo richiede circa 15 mila litri di acqua. Solo quando si conoscono queste informazioni è possibile intervenire grazie alla tecnologia sui processi con l’obiettivo di ridurre l’uso di acqua (riducendo i prelievi e/o i consumi), e in seguito riutilizzarla o riciclarla. Anche modifiche ai materiali e alle attrezzature hanno un grande impatto e possono cambiare le cose. Basti pensare che un
hamburger di soia si stima impieghi 160 litri di acqua rispetto ai 1000 litri necessari per un comune hamburger di manzo.
Il valore delle acque reflue
Le risorse idriche possono essere riutilizzate, riciclate e recuperate. La normativa, in particolare quella europea, interviene spesso positivamente in questa direzione. In particolare, la direttiva 91/271/CEE sollecita gli Stati membri a prevedere il riuso ogni volta che sia appropriato. Miceli ha segnalato come l’Enea sia intervenuta spesso per ridurre gli scarti e ottimizzare efficienza e sostenibilità dei processi grazie alla rimessa in circolo dell’acqua.
I reflui di molte industrie alimentari e lattiero-casearie diventano, nelle parole del ricercatore Enea, delle “vere e proprie miniere”. Miniere di molecole, come sieroproteine, polifenoli, antociani, acidi fenolici, che per le loro caratteristiche possono essere immessi in altri processi.
L’acqua reflua di per sé costituisce quindi un valore aggiunto e può essere trattata. Nel lattiero-caseario, in particolare, l’acqua e il suo riutilizzo, svolgono un ruolo fondamentale; basti pensare che si calcola che per ogni litro di latte prodotto, si contano 2 litri
e mezzo di acque reflue che contengono residui organici. Ma anche detergenti che vengono utilizzati per il lavaggio delle macchine; e quindi si tratta di acque che devono essere trattate.
In un caso studio sulla mozzarella per pizzeria, si è constatato che più del 50% dell’acqua è impiegata per funzioni di pulizia e igienizzazione. Nel caso dei reflui caseari, con gli opportuni interventi le cose possono cambiare e il 55% di acqua e sali minerali possono essere recuperati.
Un altro caso studio citato fa invece riferimento ai reflui enologici, campo nel quale i maggiori volumi si hanno nella fase di lavorazione immediatamente successiva alla vendemmia (oltre 5 milioni di hl/anno di acqua), seguita dalle operazioni di travaso e di lavaggio delle linee di confezionamento (rispettivamente 2,7 milioni hl/anno e 1,5 milioni hl/anno), e il lavaggio delle bottiglie (900 mila hl/anno). A livello nazionale si stima che nel 2004 ci siano stati 11 milioni di hl/anno reflui. In questi casi si tende a intervenire con strategie per diluire i reflui, attività che però implica un ulteriore utilizzo di acqua. Un intervento diverso ed efficace opera invece per cosiddetti “processi separativi”, attraverso una filtrazione tangenziale selettiva che permette di ottenere acqua “ultra pura” da immettere nel ciclo produttivo. Le tecnologie a membrana applicate alle acque di scarico di lavaggio delle bottiglie permettono di recuperare l’acqua e riutilizzarla in ciclo continuo o per altre fasi del processo produttivo, o anche per scopi di irrigazione.
Nel caso dei reflui oleari il principale sottoprodotto della lavorazione delle olive è costituito dalle acque di vegetazione, che derivano dall’acqua di costituzione della drupa e dall’acqua impiegata per la diluzione della pasta delle olive e per il lavaggio delle macchine. Si stima che la quantità annuale di acque reflue prodotte nei frantoi in Italia ammonti a circa 1 milione di tonnellate.

L’analisi chimica di queste acque mostra che sono presenti in quantità molte molecole interessanti e utili, e possono quindi essere recuperate e riutilizzate. Enea è intervenuta con processi separativi con diversi tagli molecolari ottenendo diversi polifenoli a diverso peso molecolare e un’acqua ultra-pura che il frantoio stesso ha potuto riutilizzare.
In un ultimo caso studio sui reflui della lavorazione del pomodoro, le acque in questione erano di lavaggio e di trasporto della materia prima, ma anche acque di processo, altre di raffreddamento delle scatole, di condensazione dei vapori eliminati nella concentrazione, oltre alle acque per il lavaggio degli impianti, dei piazzali e dei locali. Come è evidente, si tratta di acque con molto materiale organico. La quantità varia molto a seconda del tipo di produzione: nel caso del concentrato di pomodoro il volume di effluente è di circa 10-13 metri cubi/t di pomodoro lavorato; nella produzione di
pelati, triturati e polpe, la quantità di acqua scaricata è molto più bassa dato che il fabbisogno idrico è di soli 6-7 metri cubi/t. Un ultimo accenno merita una delle nuove tecnologie più promettenti che potrebbe avere sviluppi interessanti. Si tratta della Idroponica, con cui l’acqua viene continuamente riciclata, utilizzata in maniera meticolosa, recuperata, microfiltrata e rimessa di nuovo nel ciclo produttivo.
LA FILIERA DEI SURGELATI
Giorgio Donegani, Presidente dell’Istituto italiano alimenti surgelati (IIAS), ha approfondito il tema dell’efficienza energetica nella filiera dei surgelati, segnalando subito una tra le errate convinzioni più diffuse, quella che il settore sia tra i più energivori. In realtà, anche se è vero che esiste un problema energetico legato alla necessità di tenere gli alimenti alle giuste temperature, tutta la tecnologia del freddo lavora da sempre cercando di ottimizzare le risorse, acqua compresa, e per minimizzare l’impatto ambientale e quello strettamente correlato dei costi.
La filiera del surgelato ha visto crescere nel tempo il gradimento dei consumatori evidenziato dall’aumento del fatturato del comparto, della produzione (oltre 1 milione di tonnellate a livello nazionale) e dei consumi degli italiani che hanno superato i 17 kg pro-capite. Una peculiarità di quella che viene chiamata la catena del freddo, è che non si tratta di una filiera verticale, come accade normalmente, bensì di una filiera trasversale, con alimenti e prodotti molto diversi fra loro accomunati dalla tecnica di conservazione.

La regola generale è che, per non compromettere o alterare la qualità e la sicurezza del prodotto, la temperatura nelle varie fasi non deve mai superare -18°C, anche se esistono alcune particolari deroghe, le quali prevedono che la temperatura può essere alzata di 3°C per brevi periodi. I prodotti, pur diversi, attraversano le medesime fasi e per ognuna di esse è stato possibile, nel corso del tempo, ridurre i consumi energetici. Si stima che il settore consumi in un anno 476 mila MWh di energia elettrica e 474 mila MWh di energia termica, che corrispondono a circa 1,04 MWh per ogni singola tonnellata prodotta.
Rispetto alle fasi di produzione, nella preparazione si hanno tra il 30 e il 40% dei consumi, mentre la fase di surgelazione, quando il prodotto fresco viene portato a bassa temperatura in tempi molto rapidi, comporta un utilizzo tra il 40 e il 50% dei consumi energetici. Solo tra il 20 e il 30% avvengono invece nella fase di stoccaggio.
Due strategie per ridurre i consumi
Per ridurre il peso dell’energia le aziende del settore seguono due strade, non necessariamente alternative fra loro.
La prima è quella della riduzione dei consumi di energia per tonnellata di prodotto, principalmente grazie all’utilizzo di tecnologie innovative e operando sul fronte dell’efficientamento dei processi. Tra queste innovazioni il dott. Donegani ha citato l’uso di surgelazione criogenica che utilizza azoto liquido e CO2 che permette tempi minimi per la surgelazione. Esistono anche nuovi materiali coibentanti, come le pannellature sottovuoto o ancora, tra le innovazioni, le porte ad alta velocità nei magazzini che limitano al massimo la possibile dispersione del freddo, e nuovi tunnel di surgelazione con sensori avanzati e l’utilizzo di intelligenza artificiale e machine learning. Innovazioni, queste ultime, che permettono di regolare la produzione del freddo in relazione alle condizioni costantemente monitorate. Anche la
scelta di ottimizzare le rotte di trasporto e l’uso di veicoli refrigerati più efficienti o a zero emissioni fanno parte delle scelte che guardano alla sostenibilità e alla riduzione dei consumi energetici.
La seconda strada per la riduzione riguarda, invece, l’utilizzo di energia a basso impatto. In questo caso l’obiettivo principale è riuscire ad autoprodurre l’energia necessaria ai propri processi. Tra gli esempi citati: impianti fotovoltaici e sistemi di cogenerazione (utilizzando il gas naturale per produrre energia elettrica e recuperare energia termica). Esistono poi alcune realtà virtuose che utilizzando gli scarti e grazie a biodigestori alimentari producono del biogas da immettere nel processo: un esempio positivo di applicazione della cosiddetta economia circolare. Esistono poi alcuni sistemi di recupero del calore dai compressori e da altre apparecchiature. Infine, anche l’acquisto di energia elettrica certificata con origine da fonti rinnovabili è un utile contributo
nella stessa direzione. Si stima che nel loro insieme tutte queste misure abbiano permesso di ridurre i consumi del 2% negli ultimi 3 anni, con un risparmio complessivo di 19 mila MWh.
Un altro aspetto rilevante nel settore ci riporta al tema dei consumi di acqua che è essenziale nelle fasi di lavaggio e di preparazione dei prodotti. Le aziende sono intervenute facendo maggiore attenzione ai prelievi e con un maggior grado di riutilizzo. Se in un anno in media l’utilizzo complessivo di acqua negli stabilimenti è di circa 7.100.000 metri cubi, pari a circa 7.800 litri per ogni tonnellata prodotta, grazie a un uso attento e a sistemi di contenimento, c’è stata una riduzione di circa il 4%, ossia di 284 mila metri cubi di acqua.
Un esempio virtuoso citato da Giorgio Donegani concerne Orogel che, con un approccio sistemico, ha potenziato l’autosufficienza energetica (installando a Cesena due impianti da 4 MW che permettono di autoprodurre circa il 70% di tutta l’energia necessaria all’azienda); ha ottimizzato i processi e aumentato la capacità frigorifera per lo stoccaggio dei

prodotti (facendo attenzione alle coibentazioni, alle aperture e chiusure delle celle frigorifere oltre che all’intera organizzazione dei flussi dei processi); ha infine lavorato per implementare e migliorare la logistica (riducendo al minimo gli spostamenti tra gli stabilimenti di surgelamento e di confezionamento e i magazzini di stoccaggio esterni; ottimizzando l’utilizzo dei mezzi di trasporto e le consegne anche in termini di chilometri percorsi). Un secondo caso interessante è quello di Findus dove con oltre 4000 pannelli solari è stato possibile produrre circa 2.400

MWh di energia elettrica all’anno: in termini di impatto ambientale si traduce in una riduzione delle emissioni di CO2 superiore a 1.000 tonnellate l’anno. L’azienda sta inoltre valutando la possibilità di alzare la temperatura di conservazione degli alimenti da -18°C a -15°C: questo potrebbe portare a una riduzione del 10% del consumo energetico senza conseguenze sulla sicurezza, la consistenza, il gusto o l’apporto nutrizionale dei prodotti conservati. I progressi che il settore dei surgelati, nel suo insieme, ha realizzato negli ultimi 3 anni, sono confermati da alcuni numeri. Sul fronte dell’energia c’è stata una riduzione complessiva del 2%: potrebbe apparire poca cosa ma, in realtà, è una quantità pari al fabbisogno energetico annuo di più di 8.500 persone. C’è stata poi una riduzione del 10% delle emissioni di CO2, che equivale a quelle emesse da 350 mila auto che percorrono la tratta Milano-Roma. Infine, per l’acqua il risparmio dei consumi è stato pari al 4%, pari a più di 3 milioni di docce accese per 5 minuti.

IL SETTORE LATTIERO-CASEARIO È MOLTO ENERGIVORO. PER QUESTO, SEMPRE PIÙ AZIENDE SI ADOPERANO PER TROVARE
SISTEMI DI EFFICIENTAMENTO ENERGETICO E PER ESSERE
SEMPRE PIÙ AUTOSUFFICIENTI. NE È UN ESEMPIO IL CASEIFICIO
SASSANO CHE HA REALIZZATO UN MODELLO VIRTUOSO DI ECONOMIA CIRCOLARE E SOSTENIBILE
Le aziende del settore lattierocaseario sono molto energivore. I costi per il consumo di energia termica ed elettrica necessaria per i diversi processi produttivi, quali pastorizzazione, produzione di vapore, di aria compressa, refrigerazione etc., sono molto elevati. In particolare, l’energia termica è utilizzata per generare calore durante la pastorizzazione, acqua sanitaria calda o vapore per la sanificazione delle linee produttive, frigorie durante il processo produttivo o lo stoccaggio delle materie prime e dei prodotti finiti.

Molte sono le soluzioni che le aziende stanno adottando in ottica di risparmio energetico: cogenerazione e trigenerazione, centrali termiche e frigo di ultima generazione. Le soluzioni possono essere molteplici e sistemi integrati che prevedono l’utilizzo di più tecnologie riducono ulteriormente i consumi. Si possono per esempio installare inverter su pompe e ventilatori, implementare un sistema di controllo e gestione delle utenze, recuperare vapore per produrre fluidi caldi di processo, ottimizzare le temperature dei cicli di lavorazione, utilizzare gruppi frigo
Stefania Milanello Esperta in tecnologie alimentari e divulgatrice scientifica
e caldaie ad alta efficienza, refrigeratori ad assorbimento, bruciatori più performanti e a bassissime emissioni di Nox, scaricatori di condensa a alta efficienza, tanto per dirne alcune.
IMPIANTI DI COGENERAZIONE
La cogenerazione (CHP - Combined Heat and Power) permette di produrre contemporaneamente energia termica ed elettrica da un impianto alimentato da un’unica fonte di energia primaria derivante da combustibili fossili (metano, gasolio, biodisel e biomasse) o energie rinnovabili. Ciò consente

È possibile effettuare interventi sulle caldaie in uso per migliorarne l’efficienza, aumentando la qualità della combustione e incrementare il rendimento termico
di non disperdere nell’ambiente gran parte dell’energia, ma di recuperarla per essere riutilizzata. Turbine a gas e a vapore, cicli combinati gas-vapore, motori a combustione interna, microturbine, etc. sono tutti sistemi cogenerativi a ormai larga diffusione. Alcune aziende lattiero-casearie si spingono a utilizzare sistemi di trigenerazione, un processo in grado di fornire elettricità, calore ed energia frigorifera, grazie a cicli inversi ad assorbimento. L’alimentazione può avvenire con gas metano, derivati del petrolio ma anche con gas di derivazione agricola, oli vegetali, legnami e rifiuti.
AMMODERNAMENTO TECNOLOGICO
Alcune aziende lattiero-casearie decidono di ammodernare gli impianti già esistenti per aumentare la produzione di energia in modo efficiente. L’ammodernamento deve essere generale e riguardare non solo generatori di calore più moderni, ma anche modifiche degli edifici stessi e degli altri impianti. Le
apparecchiature per generare calore sono diventate sempre più efficienti, in grado di garantire un minor consumo di combustibile a parità di rendimento. Non sempre è necessario sostituire le caldaie vecchie con quelle più moderne. È possibile effettuare interventi sulle caldaie in uso per migliorarne l’efficienza, aumentando la qualità della combustione e incrementare il rendimento termico. L’energia nelle caldaie è in parte utilizzata per scaldare il fluido di processo (aria, acqua, vapore, etc.) e in parte dissipata nell’ambiente. Il calore dissipato potrebbe essere, invece, riutilizzato per processi termici all’interno dello stabilimento. Allo stesso modo potrebbe essere recuperato anche parte del calore, attraverso l’acqua calda già utilizzata. Le moderne tecnologie consentono alle aziende lattiero-casearie di riutilizzare energia termica che andrebbe altrimenti dispersa, di depurare gli effluenti e di abbattere la temperatura degli stessi prima del trattamento di smaltimento nella rete fognaria.
È possibile recuperare anche parte del calore su compressori attraverso il flusso di aria di raffreddamento proveniente dal compressori stessi o dal circuito di lubrificazione a olio del compressore. Nel primo caso il calore generato esce dal compressore attraverso il flusso di aria di raffreddamento, che può essere utilizzato per riscaldare diversi ambienti. Nel secondo caso il calore generato dal compressore è recuperato dal circuito di lubrificazione attraverso uno scambiatore di calore olio/acqua. In questo modo è possibile riscaldare acqua fino a circa 70°C. L’ammodernamento può riguardare anche i motori elettrici. Spesso questi funzionano in regime di on/off, non permettendo una regolazione in caso di carichi parziali, con conseguente spreco di energia. È possibile installare sistemi di regolazione, come, ad esempio, un inverter che regolando l’attività del motore elettrico, fa risparmiare ener-

L’energia termica è utilizzata per generare calore durante la pastorizzazione, acqua sanitaria calda o vapore per la sanificazione delle linee produttive, frigorie durante il processo produttivo o lo stoccaggio delle materie prime e dei prodotti finiti
gia elettrica in ingresso e migliorare la resa dell’impianto. Gli inverter possono essere installati su compressori per migliorare l’efficienza energetica nella produzione di aria compressa.
Può essere invece più utile sostituire del tutto i motori tradizionali con quelli ad alta efficienza, che hanno minori perdite e che necessitano di minore energia elettrica in ingresso. I ritorni economici sono brevi, contando che il costo legato al ciclo di vita di un motore elettrico dipende per la quasi totalità dal consumo di energia elettrica e solo minimamente dall’investimento iniziale. L’installazione di impianti di rifasamento serve invece a diminuire le perdite di energia dovute allo sfasamento tra tensione e corrente assorbita, che si crea all’aumentare delle ore di funzionamento di una macchina elettrica. Si tratta di un intervento tecnologico a basso tempo di rientro.
Le aziende lattiero-casearie necessitano di soluzioni efficienti anche per la produzione di freddo. Si può optare per chiller a compressione di vapore, con consumo di energia elettrica o per chiller ad assorbimento, in cui l’energia elettrica per alimentare il compressore è praticamente sostituita da calore a bassa temperatura (circa 90-120°C). Quest’ultima soluzione può essere la più adatta se l’azienda ha a disposizione cascami termici di processo (fumi esausti, reflui caldi, etc.) e la necessità di produrre “freddo” a temperature non inferiori ai 3-4°C, ad esempio negli ambienti di stagionatura o stoccaggio di alcuni prodotti caseari. Esiste anche la possibilità di recuperare energia termica dai cascami termici di processo, per produrre vapore, che può essere conferito a compressori, azionati mediante turbine a vapore, per la produzione di aria compressa.
La Centrale del Latte del Molise, di proprietà della famiglia Sassano, con il contributo tecnologico di Siemens, ha realizzato un esempio virtuoso di economia circolare e sostenibile per la propria azienda casearia situata nella provincia di Campobasso. Grazie a un progetto integrato che ha visto il coinvolgimento di numerosi partner tecnologici, il Caseificio Sassano è stato in grado di raddoppiare la produzione casearia, ottimizzare al massimo le risorse impiegate e ridurre considerevolmente il proprio impatto ambientale, grazie a un abbattimento di oltre un terzo delle emissioni di CO2 annue. Con un ampio progetto di ammodernamento, l’implementazione di un concentratore per il siero, di un digestore, di un cogeneratore a biogas da 380 kW, di un depuratore e la realizzazione di nuovi ambienti destinati alla produzione, locali tecnici e uffici, l’azienda molisana oggi è in grado di produrre autonomamente, tramite la valorizzazione del principale sottoprodotto dell’industria casearia, il siero, una quota significativa (circa il 40%) del proprio fabbisogno energetico giornaliero. “Il siero, principale sottoprodotto della lavorazione casearia, invece di essere smaltito viene valorizzato attraverso un concentratore”, spiega Antonella Palmieri, Responsabile Marketing e Comunicazione, Caseificio Sassano. “Grazie a un processo di concentrazione, dal siero si ottengono proteine grezze, cedute all’esterno e destinate alla produzione di integratori alimentari, acqua destinata ai lavaggi quotidiani degli impianti, una soluzione residua a base di lattosio che viene fatta fermentare in un digestore anaerobico, destinato alla produzione di biogas, destinato ad alimentare un cogeneratore utilizzato per la produzione di energia elettrica e termica destinate ai

consumi del caseificio. I vantaggi sono numerosi: nessun costo di smaltimento del siero, autoproduzione di energia elettrica (52% del fabbisogno nel 2022) e di quella termica (circa 20% del fabbisogno), minor consumo di acqua. Grazie al depuratore, inoltre, il Caseificio è in grado di recuperare l’acqua e riutilizzarla in diversi processi di lavaggio industriale”. Siemens fa sapere che, per gestire in modo efficiente tutti gli impianti e garantire la resilienza di tutti i processi, è stata realizzata una cabina di distribuzione da 2.500 kVa equipaggiata con tecnologia Siemens al 100%. Nello specifico, ci sono un quadro di media ten-
sione Siemens Simotec, due trasformatori da 1.250 kVa, un Power Center Sivacon S4 (con gli innovativi interruttori scatolati 3VA), strumenti di misura Sentron PAC e i condotti sbarre Sivacon 8PS. Una soluzione cosiddetta TIP (Total Integrated Power) che ha permesso di ottenere la massima integrazione di tutti gli asset e a tutti i livelli, dai sistemi di media tensione fino all’avviamento del singolo motore negli impianti di produzione. Infatti, tramite l’utilizzo della tecnologia IO-Link, la comunicazione tra gli avviamenti motore della serie 3RA6 e le CPU Simatic S7-1200 diventa semplice e intuitiva, così come l’implementazione a SCADA, a favore inoltre di una riduzione sensibile dei tempi di messa in servizio. Particolare attenzione è stata data alla sicurezza: il power center da 2.000 A è stato realizzato rispettando i requisiti di tenuta all’arco interno, dunque in grado di garantire un elevato livello di sicurezza per gli operatori. Ma non solo, in un’ottica di flessibilità e scalabilità, è stato dotato di basi estraibili predisposte per l’inserimento futuro degli interruttori 3WL e 3VA, una soluzione Siemens che renderà rapido e poco invasivo il successivo ampliamento tecnologico.
IL MONDO AGROALIMENTARE È AVVIATO SULLA STRADA
DELL’INNOVAZIONE MA SERVONO COMPETENZE
SPECIFICHE E FORMAZIONE, COSE NON SEMPRE FACILI DA REPERIRE. UNA RICERCA NOMISMA SI È FOCALIZZATA
SULLO STATO DELL’ARTE E I FABBISOGNI IN ITALIA
Le aziende agroalimentari italiane possiedono le competenze necessarie per portare avanti la necessaria e inevitabile transizione ecologica ed energetica? E come favorire i processi di formazione del personale e aiutare i processi di trasformazione? A queste domande ha cercato di rispondere un’indagine di Nomisma in collaborazione con Philip Morris Italia presentata a luglio 2024 durante un incontro, moderato da Paolo De Castro, Presidente del Comitato Scientifico Nomisma, alla presenza dei principali esponenti politici italiani attivamente impegnati sul fronte agroalimentare al Parlamento Europeo.

Parliamo di un contesto in cui agricoltura e industria alimentare rappresentano 77 miliardi di euro di valore aggiunto e un export che nel 2023 ha superato i 64 miliardi di euro. È evidente che le sfide della transizione ecologica ed energetica a cui le imprese agroalimentari sono chiamate non possono prescindere dallo sviluppo dell’innovazione, in particolare digitale. Per questo De Castro ha spiegato: “Se per vincere la doppia sfida della transizione ecologica ed energetica il digitale può rappresentare uno strumento importante, competenze e formazione si configurano come due leve strategiche altrettanto necessarie alle imprese agricole ed alimentari per governare

David Migliori
piuttosto che subire questa transizione, restando così al passo degli enormi cambiamenti che stanno interessando la filiera agroalimentare”.
La questione di un gap da colmare è una questione reale e ha un peso importante: l’indagine, dal titolo “Le competenze per la transizione ecologica ed energetica nelle imprese agroalimentari italiane: stato dell’arte e fabbisogni”, ha rivelato che un’azienda su quattro lamenta la mancanza di competenze specifiche e avverte la necessità di formazione per affrontare le sfide di questa transizione.
Presentata da Denis Pantini, responsabile Agroalimentare Nomisma, la ricerca ha

Le sfide della transizione ecologica ed energetica a cui le imprese agroalimentari sono chiamate non possono prescindere dallo sviluppo dell’innovazione
preso in esame i pareri di 373 aziende, suddivise in maniera omogenea su tutto il territorio italiano e, ovviamente, differenziate anche per fatturato. Ben diversificate anche le tipologie di attività, con la presenza di aziende attive nel campo vitivinicolo, nei cereali, nella coltivazione di tabacco, ortaggi, frutta, ma anche imprese dedite alla produzione di carne e latte. Un ultimo dato importante sul campione della ricerca: per il 36% si è trattato di aziende agricole con oltre 50 ettari SAU e per il 13% con un conduttore giovane, di età inferiore ai 40 anni. Numeri, anche questi, in linea con la situazione esistente in Italia.
Il punto di partenza della ricerca ha riguardato l’attuale stato della situazione sul fronte della transizione energetica, a partire dalla quota di energia rinnovabile sul totale del consumo energetico. I dati
europei dicono che l’Italia si trova in posizione arretrata rispetto alla gran parte degli altri Paesi. La media europea certifica che oggi circa il 23% dell’energia del settore è rinnovabile, con nazioni particolarmente virtuose come la Svezia (66% di rinnovabili), Danimarca (42%), ma si comportano “bene” anche Paesi mediterranei come il Portogallo (35%). L’Italia raggiunge solo il 19% di energia rinnovabile, livello che ci posiziona molto vicino a altri grandi Paesi come la Francia (20%) o la Germania (21%), ma


ben lontani dall’obiettivo del 2030 di raggiungere l’ambizioso traguardo del 42,5%.
La cosa preoccupante è che 10 anni fa la nostra quota di rinnovabili era pari al 17%, quindi la crescita dell’ultimo decennio è stata davvero minima. E anche rispetto alle competenze digitali l’Italia sconta un ritardo rispetto alla media UE, in particolare rispetto ai Paesi nordici.
Per capire a cosa ci si riferisce concretamente quando si parla di tutela della biodiversità e di energia rinnovabile nel settore agroalimentare, Nomisma lo ha chiesto direttamente ai responsabili delle aziende agricole. Le principali risposte fanno riferimento alla produzione di energie rinnovabili (13%), alla contrazione dell’uso di input chimici (12%) e alla tutela della biodiversità (11%). Seguite a breve distanza dalla riduzione dei consumi energetici e dalla tutela del suolo (entrambi al 10%).
L’altro grande tema è quello dell’innovazione digitale, che è già oggi una realtà per quasi tutte le imprese (per oltre 7 su 10), per le quali l’integrazione con macchine agricole e strumenti rende l’attività produttiva più sostenibile. Gli strumenti più utilizzati com-
prendono app e software per la gestione aziendale (46%) e quaderni di campagne digitali (39%), ma anche macchine con guida assistita e/o semiautomatiche e/o con GPS integrato (32%), centraline meteo aziendali (25%) e sistemi per il supporto alle decisioni per la difesa fitosanitaria (19%).
Le innovazioni ritenute più importanti sono i sensori prossimali per il monitoraggio del microclima, del suolo e della vegetazione (indicati dalla quasi totalità
del campione, ma utilizzato oggi solo dal 15%). Anche le centraline e i sistemi di supporto di cui poco sopra sono indicati come gli strumenti digitali più importanti.
QUESTIONE
FORMAZIONE È interessante capire quali siano i benefici che queste tecnologie permettono. Rispetto ai loro vantaggi, poco meno della metà dei rispondenti conferma che parliamo di strumenti che migliorano la produttività dell’azienda; un quarto dei rispondenti conferma che si tratta di sistemi che portano benefici economici alle attività produttive e una quota solo leggermente inferiore segnala i vantaggi anche in termini di miglioramento della qualità della produzione. Rispetto alle note dolenti, quello che emerge è la necessità di avere competenze specifiche per le quali serve una formazione ad hoc; un’analoga percentuale di persone (siamo intorno a ¼ dei rispondenti), segnala gli elevati costi legati all’adozione di queste innovazioni.
L’importanza della formazione è ormai molto evidente. Pantini nel suo intervento ha spiegato come solo l’1% consideri “poco importante” la formazione dei dipendenti e dei collaboratori; esiste un altro 10% che è tiepido e parla di “moderatamen-

te importante”, a fronte di un 45% di rispondenti che conferma di giudicare questo aspetto “importante” e un ulteriore 44% addirittura “molto importante.” Purtroppo, a fronte di questa necessità, gli imprenditori agricoli non si mostrano pienamente soddisfatti: l’attuale preparazione professionale di dipendenti e collaboratori è giudicata buona dal 33%, sufficiente dal 38% e insufficiente da 20%. In ogni caso, la buona volontà da parte del settore non manca: la metà delle imprese realizza già attività di formazione specifica (al di là della formazione obbligatoria prevista dalle varie normative).
Ma quali sono le competenze necessarie per la transizione segnalate da chi opera “in prima linea”? Il 48% segnala competenze legate alla gestione sostenibile delle risorse e per l’ottimizzazione dei processi produttivi. Molto importante, a ruota, anche l’abilità nei software di gestione aziendale (per una gestione sostenibile).
Un’altra skill segnalata come molto importante è relativa alla specifica conoscenza delle scienze biologiche e chimiche necessarie per una produzione sostenibile. Sono invece pochi quelli che, parlando di innovazione, segnalano la necessità di competenze specifiche in ambito di robotica, sensori, droni intelligenti e sistemi di irrigazione intelligenti.
Il problema principale segnalato dalla ricerca è la difficoltà da parte delle aziende di trovare risorse umane competenti. Alla specifica domanda sul livello di difficoltà nel trovare personale davvero competente in materia, meno dell’1% giudica la cosa “molto semplice” e un altro 10% non cita problemi. Ma ben il 37% segnala questo aspetto come “critico” e un ulteriore 22% parla di problema “molto critico”. E il resto? Il 22% ha rinunciato alla ricerca esterna e punta sulla formazione interna

del proprio personale e un ultimo 9% si ostina ancora a pensare che non sia importante avere risorse umane competenti nella transizione eco-energetica.
L’AGRICOLTORE IMPRENDITORE
Se la leva della formazione è l’elemento fondamentale per essere innovativi, gli accordi di filiera nel settore agroalimentare possono svolgere un ruolo fondamentale per favorire benefici a tutti gli operatori del settore. Il relativo ritardo di parte di questo mondo sulla strada dell’innovazione dipende in parte da una vecchia mentalità e da antichi errori di cui ha parlato il professore dell’Università di Perugia Angelo Frascarelli, noto ricercatore e divulgatore anche nel campo delle agricolture sostenibili. Durante l’incontro ha spiegato di non essere sorpreso dell’arretratezza dell’agricoltura sul fronte delle competenze: a suo parere ciò dipende in parte da alcuni errori del passato, in primis dall’aver continuato a considerare l’agricoltore solo come un semplice coltivatore dedito ad una attività fisica. Si tratta di retaggi di una vecchia cultura in cui si diceva “se non studi vai a zappare la terra”. Invece l’agricoltore è oggi un imprenditore e ha bisogno di possedere e padroneggiare conoscenze importanti sulle tecniche agricole, le nuove tecnologie, la contabilità e la finanza, il marketing e la comunicazione e anche la gestione del rischio, tanto più di fronte ai nuovi problemi ambientali. Senza trascurare l’importante di possedere doti di leadership e di psicologia necessarie per poter svolgere il ruolo di responsabile dell’attività di altre persone, sia collaboratori che dipendenti. Di fronte a questa “esplosione” di nuove competenze necessarie per il lavoro, diventa normale ed evidente la necessità di doversi avvalere, in alcuni casi, di consulenti specializzati. E invece troppe volte vengono considerati dei costi inutili o non necessari. Al contrario sono supporti imprescindibili quando all’interno mancano le competenze specifiche. Come ha spiegato Frascarelli: “Più che i capitali oggi contano le idee e le conoscenze, perché siamo nell’era dell’economia della conoscenza”.
Epta ha contribuito alla realizzazione del punto vendita Lidl
Italia più sostenibile di sempre, progettando un innovativo impianto di refrigerazione. Quest’ultimo si distingue nel panorama del Retail italiano in quanto composto da una centrale frigorifera a CO2 transcritica, arredi refrigerati a gruppo incorporato a propano e un sistema di recupero di energia termica, che alimenta le pompe di calore acqua-acqua per il riscaldamento e il raffrescamento dello store.
L’Insegna ha scelto di affidarsi a Epta per ottimizzare le performance della sua catena del Freddo nel primo format di supermercato del futuro, inaugurato a Villafranca, in provincia di Verona: completamente autosufficiente da un punto di vista energetico in virtù dell’installazione di un impianto fotovoltaico da 575.000 kWh/anno, e costruito con materiali riciclati, minimizza le dispersioni energetiche e le emissioni in atmosfera, per un’ecocompatibilità a tutto tondo.
Epta ha proposto soluzioni di refrigerazione naturali ed efficienti grazie a un impianto a CO2 volto a calibrare i propri parametri in funzione delle diverse condizioni climatiche e banchi a R290 a

marchio Costan, in versione Closed, per arredare tutti i reparti della superficie di vendita.
Al cuore dell’impianto si colloca una versione potenziata di Eco2Small, centrale a CO2 transcritica di media e bassa potenza, ideale per installazioni in spazi ristretti, che coniuga compattezza e modularità, consentendo numerose possibilità di configurazione. In tale contesto, la centrale si combina con un subcooler
ETE Extreme Temperature Efficiency che, attivo in caso di temperature elevate, garantisce un raffreddamento del fluido refrigerante e un significativo risparmio oltre i 40°C.
In aggiunta, l’intero sistema si fonda sul recupero di energia termica che prevede, in primavera e autunno – con temperature esterne comprese tra i 15 e i 22°C – il rilascio in ambiente dell’eccesso di calore prodotto dagli arredi, a favore di una sensibile riduzione dei consumi energetici. Infine, nella stagione invernale, al di sotto dei 15°C, un sistema di Heat Recovery permette di valorizzare il surplus di energia termica originata dai banchi, al fine di riscaldare il punto vendita.
EPTA www.eptarefrigeration.com

Le aziende alimentari hanno accelerato l’interesse per soluzioni digitali collaudate con l’obiettivo di raggiungere maggiore efficienza della filiera e riduzione dei costi. Una buona notizia questa per il gruppo CSB-System, che da oltre 40 anni fornisce software, services, hardware e business consulting alle aziende del settore alimentare. In particolare, negli ultimi anni, è stato consolidato il CSB B2B Webshop e potenziata la sua integrazione con l’ERP CSB-System, software gestionale completo e modulare.
Il CSB B2B Webshop offre una soluzione tagliata su misura per trasferire in rete gli ordini in entrata, laddove il CSB ERP svolge la funzio-


ne di piattaforma per il carrello digitale. Avere un unico fornitore di ERP e Webshop è sicuramente conveniente, perché consente all’azienda di formare gli utenti su un unico software e di avere un unico referente per i processi associati al ricevimento ordini, minimizzando le spese per personale e infrastrutture.
La possibilità di eseguire degli ordini online facilita la comunicazione tra le parti. Si pensi a un gruppo formato da tante filiali e/o negozi o rappresentanti che giornalmente eseguono degli ordini di fornitura: grazie al Webshop, anche tramite tablet, l’ordine si svolge completamente online, con notevoli risparmi di tempo. L’elevato livello di integrazione tra ERP e Webshop assicura che non vi
sia interruzione del supporto tra acquisizione delle informazioni ed elaborazione delle stesse: tutti i dati dell’ordine sono immediatamente disponibili per l’esecuzione nell’impianto di produzione, già nel momento in cui sono inseriti, senza doppie registrazioni. Si può dire finalmente addio a soluzioni a isola, doppi inserimenti degli stessi dati, problemi di interfaccia e sincronizzazioni manuali.
La comunicazione diretta dell’ERP CSB-System con il CSB Webshop assicura che la disponibilità degli articoli, i tempi di consegna e i singoli prezzi siano automaticamente garantiti al momento dell’ordine.
CSB-SYSTEM www.csb.com

Diletta Gaggia
NEL 2023 LA SPESA COMPLESSIVA PER I CONSUMI ALIMENTARI IN ITALIA HA OLTREPASSATO 290 MILIARDI DI EURO, SUPERANDO I LIVELLI PRE-COVID E ATTESTANDOSI AL 23,1% DI CONSUMI TOTALI
Nel 2023 il valore aggiunto dell’agroalimentare (agricoltura e industria alimentare) ha raggiunto 77,2 miliardi, circa il 4% del PIL nazionale. La parte maggiore, 40,5 miliardi, si deve all’agricoltura, i restanti 36,7 miliardi all’industria alimentare, ma il peso del comparto è cresciuto grazie soprattutto a quest’ultima (2% del PIL
rispetto all’1,8% del 2022) più che all’agricoltura (2,2%, dopo il 2,1% del 2022). Comprendendo la distribuzione e la ristorazione, il peso del settore raggiunge il 7,7% del PIL, che arriva al 15% includendo anche i servizi di logistica, trasporto e intermediazione legati alla filiera. Questo è quanto emerge dal “Rapporto sull’agroalimentare italiano 2024” di Ismea.
Tabella 1. Valore aggiunto per branca di attività (2023) (Fonte: elaborazioni Ismea su dati Istat)
IL CONFRONTO CON L’UE
Nel confronto con l’Europa, il valore aggiunto agricolo è cresciuto del 3,7% rispetto al 2022 a prezzi correnti, ma si è ridotto del 3,3% in termini reali. È continuata, seppur in misura molto più contenuta, la riduzione in volume dei consumi intermedi (-1,2%), conseguente allo sforzo degli agricoltori di limitare l’aumento



dei costi. La produzione agricola ha raggiunto 71,9 miliardi di euro, con un +0,4% in valore e un -2,3% in termini reali rispetto al 2022. “Non si è arrestato il calo della zootecnia (-1%), dovuto alla minore produzione di carni bovine (-2,6%) e di latte (-1,1%)”, prosegue il report. Molto meglio è andata l’industria alimentare, il cui valore aggiunto nel 2023 è aumentato del 16% a prezzi correnti e del 2,7% in volume. Tale andamento si inquadra in una dinamica molto positiva nel decennio (2014-2023), con un aumento del valore aggiunto del 45% in valore e del 26% in volume. Riguardo alla produzione, l’industria alimentare ha accusato un lieve ripiegamento nel 2023 (-1,7% rispetto al 2022) nel quadro di un trend decennale comunque positivo (+10,5%).
Il primo comparto dell’industria alimentare italiana è il lattiero-caseario, a cui si deve il 14,3% del fatturato complessivo; seguono ortofrutta (8,5%), elaborati di carni (8,1%), vino (7,6%) e macellazione di carni rosse (7,2%). Pasta e olio, prodotti di punta dell’export agroalimentare, coprono rispettivamente il 5,7% e il 5,1% del fatturato dell’industria alimentare italiana. Le dinamiche del 2023 sono positive per il lattiero-caseario (+3,4%), trainato da export e consumi interni; cioccolateria e confetteria (+1,6%), gra-
zie alla spinta della domanda estera; mangimistica (+1,9%) e panetterie e pasticcerie artigianali (+0,9%). Si riducono, al contrario, i fatturati di oli e grassi vegetali (-10,5%), industria ittica (-9,2%), carni rosse (-7,5%), succhi di frutta (-7,9%) e gelati (-8,1%).
“Guardando ai confronti con i partner europei, l’Italia detiene una quota del 16,9% del valore aggiunto agricolo dell’UE, preceduta dalla Francia (leader con il 17,4%), ma davanti a Spagna (14,7%) e Germania (13,8%)”, secondo l’analisi Ismea. Riguardo all’industria alimentare, l’Italia si conferma al terzo posto come peso sul valore aggiunto dell’UE, con una quota dell’11,9%, dopo Germania (paese leader con il 19,5%) e Francia (17,8%), ma sopra alla Spagna (10%).
Nel 2023 la spesa complessiva per i consumi alimentari in Italia ha oltrepassato 290 miliardi di euro, superando i livelli pre-Covid (circa +16% rispetto al 2019) e attestandosi al 23,1% di consumi totali. La spesa domestica ha raggiunto i 195 miliardi di euro (+8,9% rispetto al 2022), mentre la spesa extradomestica è stata di 95 miliardi di euro (+16%).
Nell’ultimo decennio la dinamica dei consumi alimentari domestici mostra una divaricazione tra la crescita in valo-
re (+3,0% medio annuo tra il 2014 e il 2023) e la sostanziale stagnazione degli acquisti in volume (+0,1%). Dal 2021 la spesa a valori costanti si è contratta a causa dell’inflazione che ha comportato una riduzione delle quantità acquistate (-3,1% nel 2022 e -0,8% nel 2023), mentre quella per alberghi e ristoranti . cresciuta vistosamente nel 2022 (+24%) per poi rallentare nel 2023 (+5%).
Secondo i dati Ismea-NielsenIQ, il carrello della spesa alimentare nel 2023 è costato agli italiani l’8,2% in più rispetto al 2022, con un incremento di circa 8 miliardi di euro; una dinamica più consistente di quella del 2022, quando la spesa era aumentata rispetto al 2021 del 6,8%, con 6,2 miliardi in più. Poiché per buona parte dei prodotti agroalimentari i volumi hanno confermato una flessione, la crescita è da ricondurre esclusivamente all’inflazione che ha spinto il valore medio dello scontrino a 23,30 euro nel 2023 (+2,6% sul 2022), dopo il +4,1% annuo del 2022.
I MERCATI ESTERI
Nell’ultimo decennio la quota delle esportazioni agroalimentari nel commercio mondiale è cresciuta dall’8,2% nel 2013 all’8,8% nel 2023, toccando il valore più alto nel 2020 (9,3%). La crescita delle esportazioni in valore, sia agroa-
limentari che complessive, ha superato il 20% nel 2022, per poi rallentare nel 2023 con il rientro dell’inflazione e il normalizzarsi dei prezzi delle commodity. Nello stesso periodo anche in Italia il peso delle esportazioni agroalimentari sul
commercio totale è aumentato, passando dall’8,6% al 10,2%. Tra il 2014 e il 2023, le esportazioni agroalimentari sono aumentate dell’87%, superando i 64 miliardi di euro; anche le importazioni sono cresciute, sebbene a un ritmo inferiore (+55%) e il
Tabella 2. Produzione dell’industria alimentare e delle bevande per comparto - variazioni % dell’indice base 2021* *variazioni calcolate sui dati corretti per gli effetti del calendario (Fonte: elaborazione Ismea su dati Istat)
analcoliche e acque minerali

saldo agroalimentare, pur restando negativo, è notevolmente migliorato.
L’INDUSTRIA AGROALIMENTARE
Nel 2023 l’industria alimentare, delle bevande e del tabacco italiana ha contribuito all’economia nazionale con un valore aggiunto di 36,7 miliardi di euro, segnando un +16,0% rispetto al 2022 a prezzi correnti e un recupero del 2,7% in volume.
Le dinamiche del decennio (2014-2023) evidenziano risultati estremamente positivi, seppure sempre con intensità maggiore in valore (+45%) che in volume (+26%). La produzione industriale, a differenza dell’agricoltura, negli ultimi dieci anni ha registrato una dinamica positiva in volume (+10,5%). Rispetto al 2019, nel 2023 l’indice della produzione industriale è aumentato del 2,7%, mentre rispetto al 2022, anno record per l’inflazione, si è verificato un ripiegamento (-1,7%), che ha visto il calo sia dei prodotti alimentari (-1,5%) che delle bevande (-4,5%) (Tabella 2). Gli unici segmenti in cui è stato segnato un incremento nel 2023 rispetto al 2022 sono stati il lattiero-caseario (+3,4%), trainato da export e consumi interni, quello della cioccolateria e confetteria (+1,6%), trainato dalla domanda estera, la mangimistica (+1,9%) e il comparto della pa-
netteria e pasticceria artigianale (+0,9%).
Al contrario, le maggiori riduzioni hanno interessato oli e grassi vegetali (-10,5%), industria ittica (-9,2%), carni rosse (-7,5%), succhi di frutta (-7,9%) e gelati (-8,1%).
La scarsa disponibilità di materia prima a livello mondiale nelle ultime due campagne è all’origine della riduzione della produzione di olio; sull’industria ittica pesa la riduzione dei volumi venduti in Italia e all’estero, mentre sul calo delle macellazioni bovine hanno influito la riduzione delle importazioni di capi da ingrasso dovuta agli elevati costi e la dinamica stagnante della domanda interna. La minore produzione di succhi trova riscontro nella ridotta disponibilità di materia prima conseguenza del calo dei raccolti delle principali specie di frutta destinate a questo segmento. Il segno negativo sulla produzione dei gelati è determinato da una riduzione dei volumi acquistati dalle famiglie, come per tutti i surgelati, essendo tra le categorie che ha subito i rincari più marcati nel 2022 e nel 2023, seppur con una tendenza al rallentamento.
L’Italia si conferma il primo paese al mondo per numero di DOP, IGP e STG, con più di 850 denominazioni tra prodotti agroalimentari (327), vitivinicoli (529) e bevande spiritose (35). Il valore della produzione italiana IG ha superato i 20 miliardi di euro (circa 9 miliardi di prodotti alimentari e 11 miliardi di vini) nel 2022 con un indotto occupazionale stimabile in circa 890.000 rapporti di lavoro. Formaggi (59%) e prodotti a base di carne (26%) rappresentano la maggiore quota del valore della produzione di cibo IG. Nel 2023 il valore di prodotti IG acquistati presso la GDO è aumentato del 7,1%, raggiungendo i 5,9 miliardi di euro, con una crescita record, dovuta anche all’inflazione.

rispetto al 2015, grazie a una crescita (45%) doppia rispetto al totale. La sua incidenza nei singoli comparti è variabile e risulta particolarmente elevata per il vino, dove arriva all’80%, i formaggi (59%) e i prodotti a base di carne (48%).
Il peso della DOP economy sull’agroalimentare nazionale è di circa il 20%, in aumento di tre punti percentuali
Le esportazioni IG nel 2022 hanno raggiunto 11,6 miliardi di euro (quasi 7 miliardi di vino e 4,7 miliardi di cibo) e sono cresciute in misura significativa (+47% rispetto al 2015), anche se a un ritmo più attenuato rispetto alle esportazioni agroalimentari nel complesso.

Paolo Bersighelli Business Developer Manager Food sector, BSI
GLI STANDARD INTERNAZIONALI SALVAGUARDANO LE AZIENDE, PROTEGGENDOLE DALLE PERDITE
DI PROFITTO ASSOCIATE A UN’AMPIA GAMMA DI MINACCE
Nel dinamico panorama del commercio globale, le aziende affrontano numerose sfide che possono avere un impatto sulla loro redditività e sostenibilità. Una delle strategie più efficaci che le aziende impiegano per mitigare i rischi e garantire l’eccellenza operativa è l’adesione agaesti standard non solo forniscono un modello per le best practice, ma fungono anche da scudo contro le perdite di profitto promuovendo la conformità alle specifiche del prodotto, nonché agli standard ambientali, di salute e sicurezza sul lavoro e al comportamento etico.
GLI STANDARD COME RICETTE
DI BEST PRACTICE
Le ricerche indicano che le aziende certificate secondo gli standard interna -
zionali sono, in media, più efficienti e redditizie del 10-15% rispetto a quelle non certificate. Ad esempio, uno studio del British Standards Institution (BSI) ha scoperto che le organizzazioni con certificazione ISO 9001 (Sistemi di gestione della qualità) hanno segnalato una maggiore efficienza operativa e migliori prestazioni finanziarie grazie alla riduzione degli sprechi e alla maggiore soddisfazione del cliente.
Lo stesso vale per la ristorazione in franchising, che secondo le statistiche hanno il 300-500% in più di probabilità di successo rispetto a piccole attività simili. La ragione principale di questo successo è l’aderenza a ricette, linee guida e standard di best practice che vengono verificati e misurati per garantire la ripetibilità e il rispetto della promessa al cliente.
Gli standard non dovrebbero essere visti come regolamenti o direttive, ma piuttosto come ricette che definiscono i sistemi, i metodi, i processi, le sequenze e le specifiche necessarie per creare un risultato desiderato. Infatti, gli standard sono fondamentali nell’implementazione di regolamenti e direttive.
Citando l’amministratore delegato della più antica azienda vinicola italiana: “Amo la mia certificazione perché fornisce la disciplina per fare la cosa giusta e un meccanismo per il miglioramento continuo”. Questa affermazione racchiude l’essenza degli standard. Si tratta di avere la disciplina per mantenere pratiche coerenti. Sappiamo tutti che, quando smettiamo di seguire una routine, che si tratti di dieta, esercizio fisico, sport, musica o processi aziendali, ci allontaniamo dal piano e le cose possono andare a rotoli.

APPROCCIO PROATTIVO VS. REATTIVO: RIDUZIONE DEI COSTI DELLA QUALITÀ
L’adozione di standard internazionali consente alle aziende di adottare un approccio proattivo alla gestione della qualità e alla mitigazione dei rischi. Stabilendo sistemi e processi solidi conformi agli standard, le organizzazioni possono prevenire i problemi prima che si verifichino, anziché reagire ai problemi dopo che si sono verificati. Questa posizione proattiva non solo riduce il costo della qualità riducendo al minimo difetti, rilavorazioni e richiami, ma migliora anche l’efficienza operativa, la sostenibilità e i profitti.
Ad esempio, l’ISO 14001 (Sistemi di gestione ambientale) aiuta le organizzazioni a ridurre al minimo i rischi ambientali,
a rispettare le normative e a migliorare la responsabilità aziendale, riducendo la probabilità di costosi incidenti ambientali e sanzioni normative. La maggior parte delle principali aziende mondiali della produzione alimentare hanno i propri stabilimenti di produzione certificati secondo i primi tre o quattro standard dell’Organizzazione internazionale per la normazione (ISO), tra cui ISO 9001 Qualità, ISO 14001 Ambiente, ISO 45001 e ISO 27001 Sicurezza delle informazioni.
Lo fanno perché ha un vantaggio economico, mitiga i rischi ed è un prerequisito per operare in determinati ecosistemi della supply chain.
Gli obiettivi di sviluppo sostenibile delle Nazioni Unite (UNSDG) forniscono un
BSI British Standards Institution - in qualità di ente di normazione - da oltre un secolo consolida best practice aiutando le organizzazioni in tutto il mondo a portare l’eccellenza al proprio interno e a costruire competenze e capacità per una crescita sostenibile. Fornisce servizi di certificazione, training e soluzioni di “customize assurance” a oltre 86.000 clienti in 193 paesi e diversi settori tra i quali il Food&Beverage. www.bsigroup.it
L’essenza degli standard: avere la disciplina per mantenere pratiche coerenti
CHE DIMOSTRANO
L’IMPORTANZA DEGLI STANDARD
1. Violazioni dei diritti umani: le supply chain globali vengono spesso esaminate per pratiche di lavoro e violazioni dei diritti umani. Standard come ISO 26000 (Linee guida per la responsabilità sociale) e altri come WRAP, ICTI, FLA, BSCI, SMETA, RBA, WCA ed ETI offrono linee guida sulla responsabilità sociale, aiutando le aziende a stabilire pratiche etiche lungo le loro supply chain. Molti retailer globali tra cui Tesco e Walmart hanno implementato solidi processi di qualificazione dei fornitori per affrontare i problemi di lavoro, dimostrando il loro impegno per l’approvvigionamento etico e riducendo i rischi reputazionali e finanziari.
2. Sicurezza alimentare: gli standard di sicurezza alimentare come ISO 22000 aiutano le aziende a gestire i rischi associati a malattie e contaminazioni di origine alimentare. Questi standard mantengono sicure le nostre catene di fornitura alimentare e prevengono i pericoli biologici, fisici e chimici negli alimenti che consumiamo, proteggendo la salute pubblica e mantenendo l’integrità del marchio.
3. Impatto ambientale: ISO 14001 aiuta le organizzazioni a ridurre al minimo il loro impatto ambientale e a rispettare i requisiti normativi, definendo obiettivi e attività volte a ridurre il loro impatto sugli ecosistemi e sulle comunità. Supportare gli obiettivi di sviluppo sostenibile globali e nazionali.
quadro per affrontare sfide globali come povertà, disuguaglianza e consumo responsabile. Aderendo agli standard internazionali, le aziende possono contribuire a questi obiettivi attraverso pratiche sostenibili, responsabilità ambientale e condotta etica all’interno delle loro catene di fornitura. Ad esempio, l’implementazione di ISO 14000 può affrontare 12 UNSDG [1, 2, 3, 4, 6, 7, 8, 9,12,13,14,15] mentre ISO 45001 può coprirne sette [3, 5, 8, 9, 10,11,16] e ISO 9001 può supportarne quattro [1, 9,12,14].
La certificazione ISO può fungere da punto di prova credibile, consentendo alle organizzazioni di soddisfare i crescenti requisiti di acquirenti, finanziatori e stakeholder.
LA CERTIFICAZIONE?
La ricerca mostra che le principali ragioni per cui le organizzazioni cercano la certificazione ISO o altri standard riconosciuti a livello internazionale sono:
1. Fiducia e reputazione migliorata: la certificazione dimostra impegno per qualità, sicurezza e pratiche etiche, migliorando la reputazione del marchio e la fiducia degli stakeholder.
2. Accesso al mercato: la conformità agli standard internazionali facilita l’ingresso nei mercati globali soddisfacendo i requisiti normativi e le aspettative dei clienti.
3. Gestione del rischio: gli standard mitigano i rischi correlati alla qualità del prodotto, agli incidenti di sicurezza, all’impatto ambientale e alle responsabilità legali.
4. Migliorare la qualità del prodotto e l’efficienza operativa: i processi standardizzati riducono sprechi e difetti, migliorano la produttività e abbassano i costi operativi.
5. Soddisfazione del cliente: il rispetto degli standard garantisce una qualità e un’affidabilità del prodotto costanti, con conseguente aumento della soddisfazione e della fedeltà del cliente.
6. Vantaggio competitivo: la certificazione differenzia le aziende dai concorrenti e attrae clienti che danno priorità all’affidabilità e
alla sostenibilità.
7. Morale dei dipendenti: gli standard promuovono un ambiente di lavoro sicuro ed etico, migliorando la soddisfazione e la fidelizzazione dei dipendenti.
8. Innovazione: gli standard incoraggiano il miglioramento continuo e l’innovazione nei prodotti e nei processi, guidando il successo aziendale a lungo termine.
9. Conformità normativa: la certificazione garantisce l’aderenza alle normative locali e internazionali, riducendo il rischio di multe, sanzioni e interruzioni aziendali.
10. Sostenibilità: gli standard di responsabilità ambientale e sociale supportano pratiche sostenibili, soddisfacendo le crescenti richieste di consumatori, investitori ed enti normativi.
La ricerca di BSI mostra che le cinque principali ragioni per adottare la certificazione sono la creazione di fiducia, il miglioramento di prodotti e servizi, la conformità alle normative, la riduzione degli errori e l’aumento del vantaggio competitivo. Tutto ciò è di buon senso.
Gli standard internazionali fungono da salvaguardia fondamentale per le aziende, proteggendole dalle perdite di profitti associate a un’ampia gamma di sfide. Che si tratti di gestire i problemi dei diritti umani nelle catene di fornitura, garantire la sicurezza e l’affidabilità dei prodotti o mitigare i rischi ambientali, l’aderenza agli standard fornisce un quadro per coerenza, qualità e responsabilità. Esempi concreti sottolineano gli impatti tangibili degli standard in diversi settori, evidenziandone il ruolo nel promuovere la fiducia, migliorare l’efficienza e garantire il successo a lungo termine in un mercato globale sempre più competitivo. Mentre le aziende continuano a districarsi in scenari normativi complessi e aspettative dei consumatori, l’adozione di standard internazionali rimane un pilastro della resilienza strategica e della crescita sostenibile che gestisce il rischio e protegge i profitti.

pronte all’uso per le conte microbiologiche per il settore agroalimentare
Conta Aerobica - E.Coli e Coliformi - Lieviti e Muffe - Coliformi,
Enterobacteriaceae - Conta Eterotrofa - Staphylococcus Aureus
Oggi sul mercato esistono prodotti simili con caratteristiche laboriose che implicano diverse problematiche, come ad esempio la preparazione del terreno, la cross-contamination, la di usione dell’aliquota e la necessità di molto spazio per l’esecuzione di numerose piastre. Molti sono i test microbiologici, ma pochi sono stati studiati per risolvere pienamente i numerosi problemi riscontrati durante le analisi.
Le Piastre Microbiologiche Peel Plate Charm presentano le seguenti caratteristiche:
- Pronte all’uso, contenenti un terreno di coltura selettivo per la crescita dei microrganismi.
- Un solo passaggio, basta pipettare il campione da analizzare senza l’utilizzo di tecniche di di usione.
- Progettate e validate per essere sovrapposte.
- Tempi e le temperature di incubazione coincidono con le convenzionali procedure microbiologiche.
-Validate AOAC e NCIMS
- ISO 9001 : 2015







